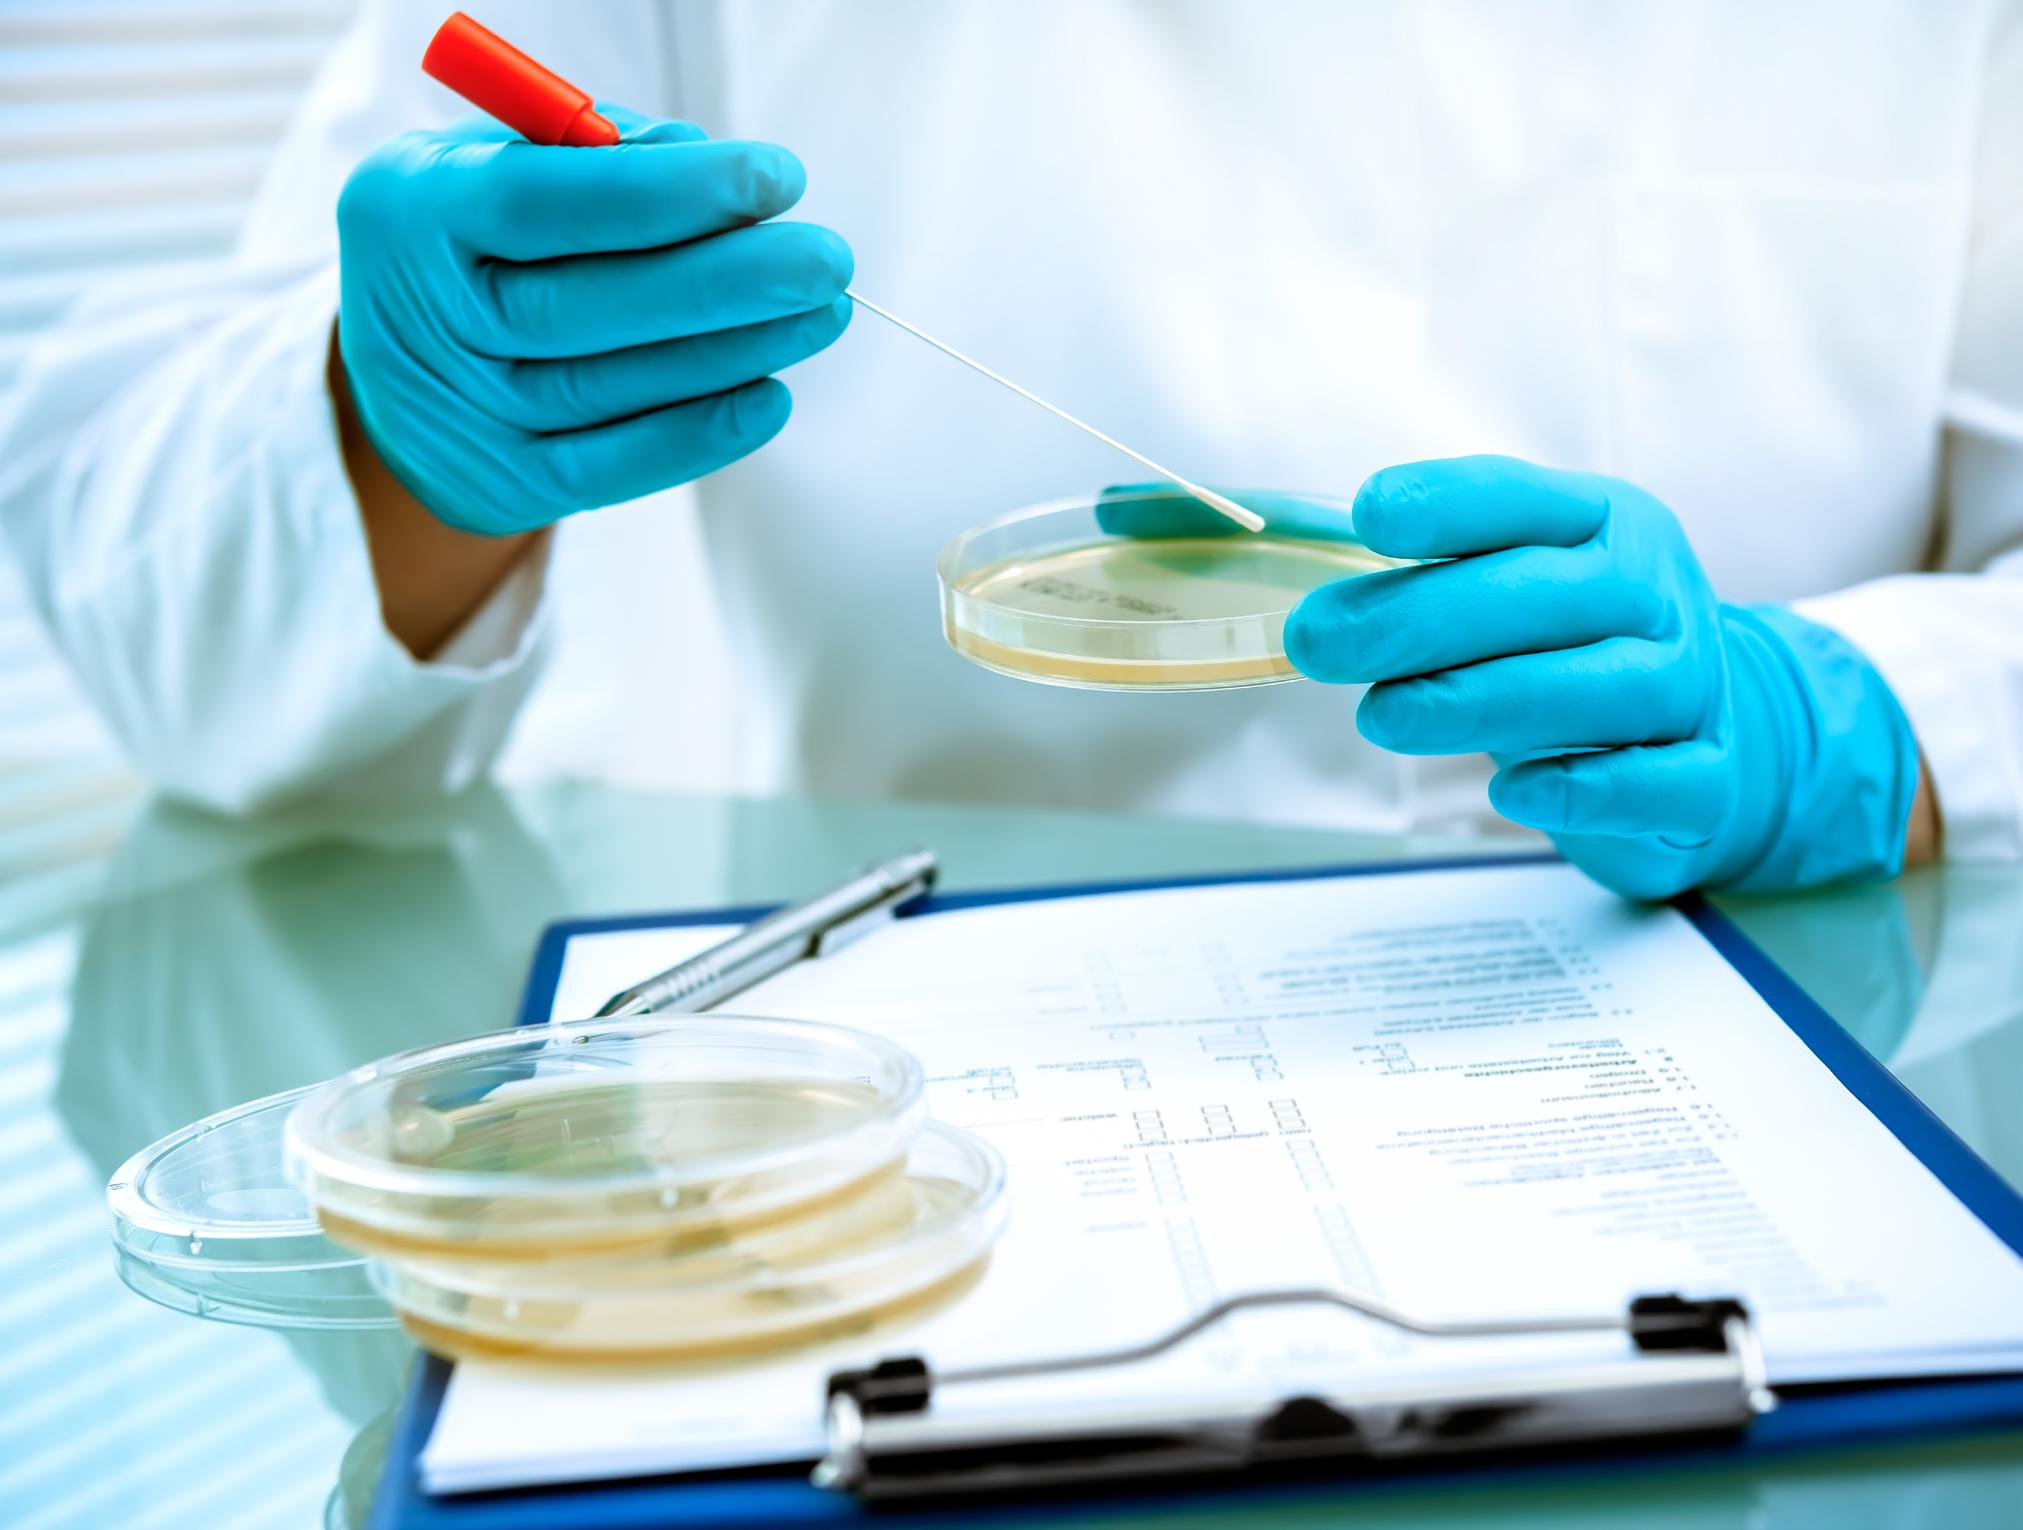

How space will feed our future

Halving
a key pillar

![]()
How space will feed our future

Halving
a key pillar


At Mérieux NutriSciences, our mission is to deliver comprehensive food safety, quality, and sustainability solutions throughout the food value chain, from farm to fork. We aim to equip the global food industry with the expertise needed to create a safer, healthier and more sustainable world.
Food safety and quality are at the core of our services. As a global leader, Mérieux NutriSciences offers extensive testing solutions to ensure food products meet the highest standards. Our services cover everything from detecting foodborne pathogens to verifying nutritional content and product stability. With over 100 food-testing laboratories across 26 countries, we support brands in maintaining quality assurance throughout their supply chains.
In Australia, Mérieux NutriSciences has been a key player since 1985, initially as Silliker Microtech. Our NATA-accredited labs in Sydney, Melbourne, Brisbane, and Perth, along with our expert teams, ensure fast and accurate results. Beyond food, we also extend our safety and quality solutions to the pharmaceutical, medical, and environmental sectors.
Mérieux NutriSciences goes beyond testing, offering consultancy services to help manufacturers and distributors develop robust food safety and quality programs.
Food Safety & Quality Management: Our consultants collaborate with clients to create personalised systems that comply with food safety standards, addressing any gaps. Our unbiased evaluations ensure that practices meet the highest industry benchmarks, safeguarding safety and quality at every stage.
Environmental Footprinting: Managing the environmental impact of food products is increasingly crucial. Our Life Cycle Assessment (LCA) and Carbon Footprinting services offer insights into the environmental performance of products and supply chains, identifying areas for improvement. We provide clients with the tools to contribute to a more sustainable food system.
Packaging: Packaging is vital in protecting products and ensuring sustainability. Mérieux NutriSciences tests packaging materials for safety and compliance, assessing their environmental impact. As the industry shifts toward sustainable solutions, our experts guide clients through the challenges of meeting
safety standards while achieving environmental goals.
Labelling & Regulatory Compliance: Accurate labelling is crucial for compliance and consumer trust. Our consultants assist clients in navigating complex food and nutrition labelling regulations, ensuring all legal requirements are met. By staying updated on regulatory changes, we help avoid mislabeling, build consumer trust and support long-term success.
Sensory & Consumer Research: Understanding consumer preferences is key to product success. Our Sensory & Consumer Research teams work with clients to enhance product sensory experiences, aligning them with brand identity and consumer expectations.
Training: Continuous education is vital for maintaining high food safety standards. Mérieux NutriSciences offers training programs for food industry professionals, covering essential topics like HACCP, environmental monitoring, and good manufacturing practices.
Outsourced Experts: Our Outsourced Experts service also provides temporary support for businesses facing staffing shortages, ensuring uninterrupted operations and maintaining high standards.
At Mérieux NutriSciences, we are your partners in building a safer, healthier and more sustainable future for the food industry. Together, we ensure that every product meets the highest standards from farm to fork.
For more information about Mérieux NutriSciences, please visit: https://www.merieuxnutrisciences. com/au/
Or submit an inquiry through our contact page at: https://www.merieuxnutrisciences. com/au/contact/ and our friendly team will contact you shortly.






12 How space will feed our future
How space food systems can contribute to building food security on Earth
14 Edible insects: from alternative proteins to adverse reactions
Allergen detection is essential to ensure food safety
20 Australian native plants: can we do better on the food market?
Considerations for integrating Indigenous foods into mainstream diets
24 The potential of seaweed-plant protein conjugates for functional food applications
Demonstrating the use of seaweeds to improve plant proteins via Maillard conjugation
28 Meat vs. meat analogues: a sensory comparison of commercial burgers Study provides valuable insights to guide development of plant-based meat products
32 Food safety: navigating ongoing challenges
Ensuring a safe food future - looking back to help us look forward
35 Halving food waste requires a $135 million investment and collaboration from paddock to plate
Strategic plan provides a clear path to turning the tide on food waste
38 Unveiling the aromatic secrets of Australian pineapple
Advanced analytical method enables identification of key aroma volatiles
40 Stepping into the future: leaving no one behind by improving food safety and health Food safety is central to achieving UN Sustainable Development Goals
44 What do packaging technologists do?
Insight into the world of the packaging technologist
45 Understanding shelf-life differences between vacuum-packed lamb and beef Winner of the 2024 AIFST Research Poster Competition
46 Validating Jade perch as Australia’s offering for a white flesh fish product Runner up in the 2024 AIFST Research Poster Competition

Published by The Australian Institute of Food Science and Technology Limited.
Editorial Coordination
Melinda Stewart | aifst@aifst.com.au
Contributors
Dr John P. Bowman, Dr Andrew Costanzo, Dr Lukas Danner, Dr Dan Dias, Dr Flavia Fayet-Moore, Dr Rebecca Forster, Jenson George, Ian Hayes, Dr Melanie Hand, Brittany Harriden, Claudia Hartley, Dr Shaymaviswanathan Karnaneedi, Dr Chawalit Kocharunchitt, Dr Steven Lapidge, Simi Lewin, Dr Andreas Lopata, Deon Mahoney, Dr Rishi Ravindra Naik, Dr Nenad Naumovski, Dr Nelum Pematilleke, Dr Laura Rood, Dr Cordelia Selomulya, Dr Heather Smyth, Dr Costas Stathopoulos, Elerin Toomik, Dr Ha Truong, Dr Yong Wang, Frances Warnock.
Advertising Manager
Clive Russell | aifst@aifst.com.au
Subscriptions
AIFST | aifst@aifst.com.au
Production Bite Communications
2025 Subscription Rates ($AU)
Australia $152.50 (incl. GST)
Overseas (airmail) $236.50
Single Copies (Australia) $38.50 (incl. GST) Overseas $59.50.
food australia is the official journal of the Australian Institute of Food Science and Technology Limited (AIFST). Statements and opinions presented in the publication do not necessarily reflect the policies of AIFST nor does AIFST accept responsibility for the accuracy of such statement and opinion.
Editorial Contributions
Guidelines are available at https://www.aifst.asn.au/ food-australia-Journal
Original material published in food australia is the property of the publisher who holds the copyright and may only be published provided consent is obtained from the AIFST. Copyright © 2018 ISSN 1032-5298
AIFST Board
Chair: Dr Michael Depalo
Deputy Chair: Dr Gregory Harper
Non-executive directors: Dr Angeline Achariya, Dr Anna Barlow, Mr Marc Barnes, Dr Heather Haines, Ms Melissa Packham.
AIFST National Office
PO Box 780
Cherrybrook NSW 2126
Tel: +61 447 066 324
Email: aifst@aifst.com.au
Web: www.aifst.asn.au
The theme of the 2024 AIFST Convention held in August, Food Science – Navigating Our Future – focused our attention on the importance of collaboration. As a food science community, we know that no one discipline, or organisation, can solve the complex challenges facing the food system we support. Keynote speakers at AIFST24 made it clear the future of food science will be defined by our ability to work together across disciplines, sectors and borders. From discussions on space agriculture to food safety, the message was clear: we must innovate together, by leveraging the interdisciplinary nature of food science, if we are to shape the future.
Key takeouts from convention streams included:
• Health and nutrition – innovations in health and nutrition are shaping public health in ways we couldn't have imagined a decade ago
• Innovation - thrives at the intersection of disciplines
• Food safety – we have the tools and knowledge to advance food safety and protect consumers
• Advanced food manufacturing - we need to harness the food innovation ecosystem to address consumer needs (from AI in food manufacturing to tomorrow’s ethical and sustainable consumer preferences)
• Sustainability - food and agriculture are setting science-based targets, but collaboration back up the supply chain is key
• Food policy and regulation – collaboration with food scientists is key to the innovation process. We need to share often and early!
• Future opportunities - we operate in a world that is infinitely surprising and we must be ready to deal with the unexpected. One of the highlights of the Convention was the opportunity to network – seeing delegates at all different stages of their careers and experiences come together reminds us that fostering connections is one of our most important roles. These connections are the lifeblood of our industry’s future.
Looking ahead to AIFST25 in Melbourne on 12th and 13th August, I am confident that we will continue to champion a science-based, innovative, and sustainable food industry.
As this is the last edition for 2024, on behalf of the AIFST team and Board, I would like to thank all our journal contributors, Scientific and Technical Advisory Committee members, event partners, members, and the wider agri-food industry community, for your support during what has been another busy and rewarding year.
Fiona Fleming
B. App Sc (Food Tech); MNutr Mgt; FAIFST Chief Executive Officer fiona.fleming@aifst.com.au

The Office of the Gene Technology Regulator (OGTR) has released the results of its most recent survey of community attitudes towards gene technology in Australia.
Conducted in 2024, the research sought to analyse current community attitudes and examine the longitudinal data to determine if and/or how community attitudes may have changed over time, including any impact from the COVID-19 pandemic.
Survey participants were asked a range of questions on genetic modification (GM), synthetic biology, animal cloning, gene editing and biotechnology. The study was designed to:
• Explore current awareness, attitudes and understanding towards general science and technology, genetic modification, specific biotechnology issues and specific applications and controllers of the technology
• Explore differences in awareness, perceptions and attitudes according to key demographic variables such as age, gender, location and education, and in terms of mindsets to determine segments in the community
• Understand if the COVID-19 pandemic has a long-lasting influence on attitudes towards genetic modification. Support for genetic modification remains stable, with 38% of the community in support of its use in general.
Levels of support are however different for different applications with the greatest support for its use being in generating therapeutics or medicines (45%). This is followed by its use in crops (42% support), food (40%), gene editing (37%) and finally in the cloning of animals (30%).These results are similar to those found in 2019.
When prompted with questions on specific potential uses of GM support differs, most notably, for food and crops where support has reduced from 44% in 2021 to 36% in 2024.
42% support the use of GM in general
40% support GM foods BUT 24% are completely against it
52% have ‘some concerns’ about GM foods and crops
36% are COMPLETELY SUPPORTIVE of the use of genetic modification and gene technology in food and crops
32% are willing to eat genetically modified fruits and vegetables
29% are not
50% have not heard of synthetic biology
Source: Office of the Gene Technology Regulator (2024) Community attitudes towards gene technology. https://www.ogtr.gov.au/resources/publications/community-attitudes-2024-report
Dr Suwimol Chockchaisawasdee joined Murdoch University in July as a Senior Lecturer in Food Science and Nutrition. Her role is to enable the teaching and research activities of the Master of Food Science, a new program commencing at the Food Innovation Precinct WA (FIPWA). Her appointment also aims to strengthen research and collaboration between the University and the Western Australian food industry.
Suwimol has more than 20 years of experience working in multidisciplinary teams in various capacities in many academic institutes in Southeast Asia, the Middle East and Europe. Recent appointments prior to joining Murdoch include a role as Senior Researcher at the Czech University of Life Science Prague, as Associate
In July, Dr Costas Stathopoulos joined the Future Foods Institute of Murdoch University as Professor of Food Science. The appointment aims to strengthen efforts by Murdoch University, the Future Food Systems CRC and the Western Australian Government to support food innovation in WA, with a particular focus on research.
Costas has more than twenty years of experience in academia and the research sector, having worked in the UK, Thailand, Ireland, Australia, South Korea, UAE and most recently Czechia, where he was ERA Chair of Food Science and Technology. He brings extensive research expertise to the team, having published more than 100 peerreviewed articles and secured more than $20 million in competitive research funding.
Professor in Food and Nutrition Sciences at Abu Dhabi University in the UAE, and as Senior Food Technologist at Abertay University in Scotland.
Suwimol’s research interest is in functional foods, especially upcycling food industry by-products to use in the development of functional food and enhanced-function packaging. Her previous research involved working with small food manufacturers to add value to local fresh produce and increase market access. Her research also included the recovery of bioactive compounds from food industry by-products and the development of functional edible films. While working in the Czech Republic, Suwimol focused on the recovery of bioactive compounds from brewers’ spent grains by using green
Additionally, Costas has been a Fellow of IFST in the UK for more than a decade and is a member of the Greek Institute of Food Science and Technology, where he has served on the Scientific Advisory Committee since 2017. He has also served on the Scottish Parliament's Cross-party group ‘Food’, acted as an expert evaluator for the Cyprus Agency of Quality Assurance and Accreditation in Higher Education, and was an expert reviewer for the British Council, ARC and the Chevening Foundation. Costas is a Life Member of the Society of Dairy Technology in the UK and has held an Adjunct Professor position with the University of Canberra since 2016.
This new role at Murdoch University will enable Costas to spearhead research efforts, while

extraction techniques. The recovered compounds are to be further used in food applications. Based at FIPWA in Nambeelup, Suwimol will collaborate with the regional food sector in WA, expanding Murdoch’s networks in the region and helping to strengthen the local economy.

also making contributions to teaching in the new MSc in Food Science. He will guide younger academics and mentor the next generation of food scientists and technologists in the new Murdoch Food Centre, which is part of the Food Innovation Precinct Western Australia (FIPWA) in Nambeelup.


Confectionary industry leader, Don Jarman passed away in July this year, aged 96.
Don began his working life in 1945 with Kia Ora Limited, working as a laboratory assistant and progressing over the next five years to laboratory supervisor.
Following his time with Kia Ora, Don worked for several years at Mauri Brothers and Thompson Limited before moving in 1952 to Sweetacres Limited/Rowntree Hoadley Limited in Roseberry, NSW.
Don remained with Sweetacres/Rowntree Hoadley for 26 years. Starting as a management cadet, Don held several roles including Chief Chemist from 1956-1970; Production Manager from 1970-1974 and ultimately General Manager of the factory from 1974-1978.
After leaving Sweetacres/Rowntree Hoadley, Don established his own management consultancy and worked with many food manufacturers specialising in audits and staff training.
In 1983, Don took on a part-time appointment as Technical Manager at World’s Finest Chocolate, where he stayed for the next 11 years.
In recognition of his significant contribution to the confectionery industry, Don was awarded the 1994 Alfred Stauder Award for Excellence.
Don was active in numerous industry groups throughout his career, including Confectionery Manufacturers Australia, the NSW Food Technology Association Management Committee, the Technical Committee Council of Australian Food Technology Associations, the Course Advisory CommitteeBiological Sciences - at Sydney Technical College and the Management Committee for the NSW Manufacturing Confectioners Confederation.
Described as “one of the confectionery industry’s true gentlemen,” Don will be sadly missed.





• Containers
jars
tubes
measuring vessels
plates and dishes
blender bags
spoons
spatulas and scoops
crushers
stirrers,
blenders
shakers
centrifuges
balances
homogenisers
hot plates
digesters
water baths
extractors. • Wet chemistry • chromatography
filtration and electrochemistry
• buffers
acids
solvents • volumetric solutions standards • indicators • allergens • quantitative and qualitative analysis
general microbiology
• pathogenic organism analysis.
3. MICROBIOLOGY
• Dehydrated media / pre-poured plates • enzymatic kits • colony counters • microscopes
• spectrophotometers • Adenosine Triphosphate (ATP) tests. For accuracy and professionalism































The annual AIFST Awards ceremony was held on Tuesday, August 6, at AIFST24 in Sydney. It was a wonderful evening during which we were able to acknowledge our award winners in person, celebrate their achievements, and appreciate the depth of talent within the Institute and the agrifood industry in Australia.
Congratulations to all our 2024 award winners and all those who were nominated. We also extend a sincere thank you to all our judges, who contributed hours of their time and expertise during the selection and judging process.

This award is named after Dr Keith Farrer OBE, a pioneering scientist and author, who was involved in the formation of AIFST in 1967. It is AIFST’s highest honour, acknowledging an individual whose work has resulted in significant positive change for the food industry, the food science and technology profession, food research and innovation, and food science education, as well as work that has promoted the health and enjoyment of food among the wider community. The recipient’s achievements must also include substantial contributions made to further the aims and objectives of AIFST. The 2024 recipient of the AIFST Keith Farrer Award of Merit is Associate Professor Vicky Solah from Murdoch University. Over her 36-year career, Vicky has shown dedication, commitment to excellence and innovation in industry-linked education, mentoring and research. Vicky’s research has contributed to the development

of grain-based food knowledge, including how dietary fibre influences postprandial glycaemia and satiety. Vicky leads by example and has trained a whole generation of food scientists. There are few food scientists in Western Australia who have not been positively impacted by Vicky’s mentoring. In 2020, Vicky returned from retirement to lead the development of Murdoch University’s Bachelor of Food Science and Nutrition, and Master of Food Science programs. She also joined the Food Innovation Precinct WA initiative to help it in its goal to build an enabling environment, using education and research as a focal point for food innovation in Western Australia. Vicky was made an AIFST Fellow in 2008 and a lifetime Fellow in 2018.
The full citation for Associate Professor Vicky Solah can be found on the AIFST website: https://www. aifst.asn.au/aifst-annual-awards.
The AIFST President’s Award honours an individual or an organisation that has made an
outstanding contribution to the Institute.
The 2024 winner of the AIFST President’s Award is Annesley Watson. Since joining the Institute as a student in 1973 Annesley has demonstrated a clear commitment to advancing AIFST’s role in supporting food industry professionals.
Annesley has been an active member of the NSW Branch Committee, co-founder of the NSW Branch Sensory Group and committee member of the National Sensory Special Interest Group.
Annesley participated in the development and piloting of the current AIFST Mentoring Program and has both formally and informally mentored many young members.
Annesley has supported the Australian & New Zealand Sensory Symposium (organising committee) for sensory students and professionals for a number of years. She served as the editor of the NSW Branch Tuckerbox Newsletter from 2000 – 2004, and was the AIFST representative on Standards Australia FT022 – Sensory Methods Committee

from 1982-2005.
Annesley has contributed to bettering the understanding and application of consumer and sensory science in academia, industry and secondary schools via a range of activities and courses.
In 1999 Annesley joined with Graham Bell to publish the book Tastes and Aromas: The Chemical Senses in Science and Industry.
Annesley has also been a member of the AIFST Membership Engagement and Development Committee, and has given many hours in developing and analysing AIFST member surveys, the latest in 2022. Following the most recent survey, Annesley conducted focus groups with members from each membership category and the findings from these surveys and focus groups have contributed to the Institute's strategic plans.
The full citation for Annesley can be found on the AIFST website: https:// www.aifst.asn.au/aifst-annual-awards.
This award acknowledges a significant new development in a process, product, ingredient, equipment, or packaging that has achieved successful commercial application in any sector of the Australian food industry. It is given in honour of AIFST Past President,

Peter Seale who held the role from 1973-75.
The 2024 winner of the AIFST Peter Seale Food Industry Innovation Award is Vortair Pty Ltd, for their innovation Vortair Fine Grinder.
The judges were impressed by the breadth of the potential applications for this low-heat mill, for its capacity to reduce food waste by converting food waste streams to usable human and pet food ingredients.
It is already in use for fish waste applications and is being trialled by numerous other industry stakeholders, indicating that it is a true technical innovation that can address unmet industry needs.
It is an Australian innovation that can benefit the food industry in Australia and globally, by helping to reduce food waste, improve food industry sustainability and through the development of new food ingredients.
The award was accepted by Tom Debney, Vortair Pty Ltd.
The Foodbank Hunger Hero Award recognises a person or team going ‘above and beyond’ to tackle food insecurity. Whether it’s championing a new initiative within their company or volunteering their time and expertise in the community, the award recognises an individual’s or team’s
contribution to inspiring others.
The 2024 winner of the AIFST Foodbank Hunger Hero Award is Bill Quayle from Rinoldi.
Bill is a longstanding advocate and supporter of Foodbank and has worked to ensure the supply of in-demand products to Foodbank across the country.
Bill has been a key driver of Rinoldi’s participation in Foodbank’s procurement programs, with a focus on the Collaborative Supply Program, and has been one of the industry’s biggest and ongoing supporters of the Foodbank procurement programs.
Rinoldi supplies the pasta as a part of multiple collaborations on different products. This helps ensure the regular supply of pasta and long-life products, key staples in supporting communities throughout the year.
This award has been created in memory of Dr David (Dave) Roberts to encourage and support the development of a young food scientist, technologist or nutritionist for their endeavour or achievement and leadership potential within the food industry.
The 2024 award winner is Dr Rishi Ravindra Naik, UNSW Sydney.

The AIFST Sensory Award is open to young members of the Institute (under 35), including undergraduate and postgraduate student members, who demonstrate an interest and passion for sensory research. The award is sponsored annually by Sensory Solutions, in honour of Anthony (Tony) Williams.
The 2024 winner of the AIFST Sensory Award is Mr Chao Xue, The University of Queensland for: Enhancing Juiciness in PlantBased Meats: Insights from Sensory Evaluation, Structural Differences and Oil Distribution.
Thank you to Sensory Solutions for your ongoing support of this award.
This award recognises the work of AIFST members who contribute to food science and technology through published research and technical papers.
The winning paper for 2024 was: Properties of sodium caseinate as affected by the β-casein phenotypes, Journal of Colloid and Interface Science, Volume 626, 2022, pp. 939950.
Authors: Davor Daniloski, Noel A. McCarthy, Martin J. Auldist, Todor Vasiljevic.
The award was accepted by Dr Davor Daniloski.

This award recognises the work of AIFST members who contribute to the literature on food science and technology through authored books or substantial reviews.
The 2024 winner is: Improvements of plant protein functionalities by Maillard conjugation and Maillard reaction products. Crit Rev Food Sci Nutr. 2022;62(25):70367061.
Authors: Rishi Ravindra Naik, Yong Wang and Cordelia Selomulya.
The award was accepted by Dr Rishi Ravindra Naik, UNSW Sydney.
This competition provides a space for food scientists to present a summary of their recent work or a key aspect of their work in poster form. The challenge for entrants is to effectively communicate and justify the key learnings of their work to an interested scientific audience.
The platform for the 2024 competition was virtual, providing an opportunity for scientists from all over Australia to share their research.The research topics encompassed a broad range of interesting and engaging subjects and spanned a wide range of disciplines. Posters were presented in a clear and eye-catching way with data presented in a thoughtful narrative. The judges would like to
thank and commend all participants in the 2024 AIFST Convention Research Poster Competition.
The winner of the 2024 AIFST Research Poster Competition is: Use of metabolomics to uncover shelflife differences of vacuum-packed beef and lamb.
Authors: Elerin Toomik, Laura Rood, Richard Wilson, John Bowman and Chawalit Kocharunchitt.
The award was accepted by Elerin Toomik, University of Tasmania.
The runner up of the 2024 AIFST Research Poster Competition is: Validating Jade perch as Australia’s offering for a white flesh fish product.
Authors: Nelum Pematilleke, Damian Espinase Nandorfy, Emma Lundin, Lukas Danner, Chris Stratford, David Blyth, Artur Rombenso, Polly Hilder, Cedric Simon, Aarti Tobin and Ha Truong.
The award was accepted by Nelum Pematilleke.
Thank you to SQF for your ongoing support for this award.
Professor Heather Smyth was elevated to the status of Fellow of the Institute at the AIFST Convention in August 2024. Congratulations to Professor Smyth.
A renowned flavour chemist and sensory scientist, Professor Smyth has significantly contributed to the premium food and beverage industry in Australia and internationally over the past two decades. She is Professorial Research Fellow (Flavour and Sensory Science), at the Centre for Nutrition and Food Sciences and Deputy Director of Research at Queensland Alliance for Agriculture and Food Innovation (QAAFI) at the University of Queensland.
Professor Smyth has dedicated her career to understanding and enhancing consumer enjoyment of foods and beverages through their sensory properties and composition. Her expertise lies in describing and articulating food quality,
understanding flavours of Australian produce, and modelling food flavour and textural properties using instrumental measurements.
Professor Smyth’s research has been pivotal in defining unique flavours of Australian products, which has helped position Australia as a supplier of premium quality foods and beverages in global markets. She has published extensively, contributing to books and journals on topics ranging from wine, coffee and seafood quality to the unique flavours of Australian native plants.
Smyth is passionate about the development of students and the mentorship of early career researchers. Her dedication has produced more than 30 higherdegree students who have gone on to successful careers spanning the food industry, government and academia.
Professor Smyth has been an active member of AIFST since 2008,
A social audit is one of the best ways to understand the working conditions at a supplier site and demonstrates to customers and stakeholders your role and commitment to ethical and sustainable practices while ensuring the continuity of your operations.
SMETA and Fair Farms are leading industry Social Compliance audits, assessing sites based on its organization’s standards. The goal is to protect workers from unsafe conditions, overwork, discrimination, low pay, and forced labour.

serving in various volunteer roles. Notably, she chaired the scientific committee for the AIFST-NZOZ Sensory and Consumer Science Symposium in both 2018 and 2022. She is an active member of the AIFST Sensory Special Interest Group, contributing to AIFST events promoting sensory science. Her leadership and dedication to AIFST have significantly advanced the field of food science and technology in Australia.


The exploration of space has always pushed the boundaries of human knowledge and technology. While space technology is often celebrated for its advancements in communication and transportation, its contributions to food systems and nutrition are equally profound. As humanity looks toward feeding a global population of 10 billion by 2050, the innovations born out of space exploration will likely play a pivotal role in ensuring food and nutritional security on Earth.
The influence of exploration on food is not a new phenomenon. In fact, the first clinical trial in nutrition was conducted in the late 1800’s, during the age of maritime exploration. Scurvy, or the deficiency of vitamin C, killed more sailors on long voyages than all other diseases combined. In 1747, James Lind, a medical officer in the British Royal Navy, conducted a study on 12 patients with scurvy onboard the HMS Salisbury.1 He divided the patients into two groups and gave each group a different remedy. Only the group given oranges and lemons recovered. In 1753 in his Treatise on Scurvy, 2 he stated that scurvy could be cured by
lemon juice in controlled experiments, and it took another 50 years before the navy mandated the use of lemon juice.
Just as the needs of sailors drove nutritional discoveries, space exploration has spearheaded major advancements in food technology. Early space missions required food that was lightweight, shelfstable and nutritious, leading to the development of freeze-dried foods that could be reconstituted with cold water in under 10 minutes.3
This technology has since become common in food preservation; from emergency food relief to meals for the military, outdoor recreation, baby foods, plant-based food innovation and even treats for our pets!
Space exploration offers valuable insights and technologies that could help meet the demand for sustainable, nutritious and delicious food for another two billion people. One innovation that has shaped our food system today is The Hazard Analysis and Critical Control Points (HACCP) system, a preventive approach to food safety that originated from the National Aeronautics and Space Administration (NASA)'s need to ensure the safety
Words by Dr Flávia Fayet-Moore
of food for astronauts.4 HACCP has evolved since its NASA days, but its rigorous focus on identifying and controlling potential hazards has been instrumental in reducing foodborne illnesses worldwide, which will continue to be a priority as we feed the growing population.
Cellular agriculture, a product of biotechnology that allows for the production of meat in a lab without the need for livestock, was technology initially funded by NASA with the constraints of space travel in mind, and there have already been meat cells grown on the International Space Station (ISS). Space agencies worldwide (NASA, ESA, CSA, JAXA) continue to fund cell-cultured meat projects. Another promising food development is the production of air protein,5 which uses a fermentation process to convert carbon dioxide into protein. This process, using original NASA technology, has the potential to create a new, sustainable food source that requires minimal land and water.
Maintaining an astronaut’s nutrition as they venture further into space becomes more difficult than on the ISS, as the food system will not have a feasible means to re-supply during the mission. 3D printing of food is a potential solution, and yet
another space-derived technology with significant implications for Earth.6 Originally developed to provide astronauts with customisable, nutritious meals, 3D food printing could offer new ways to reduce food waste and create personalised nutrition solutions tailored to individual dietary needs. The inputs for the food could range from the Animal kingdom (fast-growing and nutritious insects), the Fungi kingdom (highly adaptable, nutritious and fastgrowing mushrooms and yeast) and even the Protista kingdom (algae, providing a further carbon sink in food systems).
The unique hazardous environment of space provides opportunities for discoveries that could enhance food production and nutrition on Earth. Microgravity, for example, alters the way plants grow, offering insights into plant biology that could lead to improved crop yields and resilience on Earth. Space agriculture, which involves growing crops in space, is pushing the boundaries of what is possible in controlled environment agriculture, from vertical farms to novel plant species for nutrition (eg. duckweed, or ‘space lentil’). The space environment also offers opportunities to study the effects of foods and supplements in an accelerated human ageing model, thanks to radiation, microgravity, confinement and isolation experienced by astronauts.7 The closed-loop ecosystems necessary for long-duration space missions offer another opportunity for food system innovation. These systems recycle air, water and waste, creating a self-sustaining environment that minimises input and outputs. On Earth, adopting similar closed-loop principles in rural and remote regions could enhance sustainability in agriculture, reduce the environmental impact of food production, and increase access to safe, nutritious and sustainable foods. Space tourism, a growing industry,

The importance of the study of the history of medicine lies in this. By it we reach some understanding of the present, and we have some chance of predicting the future.
Sudhof and Sigerist-Lee
also presents new challenges and opportunities for food production. As more people venture into space, the demand for high-quality, nutritious and enjoyable food will increase. This demand could drive further innovation in food production and preservation technologies that could benefit both space travellers and people on Earth.
The commercialisation of space, referred to as New Space, brings with it significant economic potential.8 Private companies are increasingly involved in space exploration, and this shift opens new avenues for innovation in food technology. The development of space-based foods and food production facilities could create new markets. Additionally, the collaboration between space agencies and private enterprises could accelerate the transfer of space technologies to Earth, and of Earth technologies to space, enhancing food security and sustainability.
Space exploration has already made significant contributions to our food systems. As we face the challenge of feeding 10 billion people by 2050, the technologies and insights gained from space exploration will
be crucial. By leveraging space food systems, advanced biotechnologies and farming and the potential of New Space, we can create a more sustainable, resilient and secure global food system. Space will not only feed our future in our galaxy but will also play a vital role in feeding our future on planet Earth.
1. Carpenter KJ. (1988) The History of Scurvy and Vitamin C: Cambridge University Press
2. Bartholomew M. James Lind's Treatise of the Scurvy (1753). Postgrad Med J 2002;78(925):695-6.
3. National Aeronautics and Space Administration. (2015) Space Food. Houston, Texas.
4. Mortimore S, Wallace C. (2013) HACCP: A Practical Approach: Springer US.
5. Air Protein Inc. Air Protein USA2024 [Available from: https://airprotein.com/.
6. Zhang JY, Pandya JK, McClements DJ, Lu J, Kinchla AJ. (2022) Advancements in 3D food printing: a comprehensive overview of properties and opportunities. Crit Rev Food Sci Nutr.;62(17):4752-68.
7. Dakkumadugula A, Pankaj L, Alqahtani AS, Ullah R, Ercisli S, Murugan R. (2023) Space nutrition and the biochemical changes caused in Astronauts Health due to space flight: A review. Food Chem X.;20:100875.
8. Corrado L, Cropper M, Rao A. (2023) Space exploration and economic growth: New issues and horizons. Proc Natl Acad Sci U S A.;120(43):e2221341120.
Dr Flávia Fayet-Moore is a nutrition scientist, space nutritionist and CEO of FOODiQ Global, a global leader in the translation of food and nutrition science. She is an Adjunct Lecturer at the University of Newcastle. f This article is based on the author's presentation at the AIFST Annual Convention, August 2024.
Words by Dr Andreas Lopata and Dr Shay Karnaneedi

The world’s increasing population is leading to a growing shortage in our mainstream food protein supply.1,2 Due to global resource constraints and climate change mitigation putting limits on traditional animalderived protein production, various alternative and innovative solutions have been identified in the past decade to supplement the global dietary needs including insects, algae and culture-grown foods.2,3 Among these, edible insects such as crickets, silkworms, mealworms, locusts and grasshoppers seem very promising.
Entomophagy (the practice of eating insects) is a very old food practice dating back to our ancestors and is still a traditional practice in many cultures worldwide particularly on the Asian, African and South American continents. In the past decade, however, younger generations have made entomophagy and alternative food production a growing cultural change.2 With over
2,000 insect species consumed worldwide, some of these insects are increasingly used in modern food products and supplements, including protein powders, energy bars, pasta and whole insects as snacks and tapas. In many of these insect food products gaining popularity among younger consumers, crickets (Acheta domesticus) are increasingly utilised.4
Edible insects are readily available to be purchased from Australian health food and fitness supplement shops. In 2018, the Food Standards Australia New Zealand’s (FSANZ) Advisory Committee for Novel Foods (ACNF) assessed and declared three insect species as safe for human consumption and able to be sold in the Australian market. The species were A. domesticus cricket, Tenebrio molitor mealworm, and Zophobas morio mealworm. Crickets and mealworms are among the most farmed edible insects in Australia, Asia and Europe. Singapore, which is highly invested and at the forefront
of alternative food protein research, has recently approved 16 species of edible insects for consumption.
Edible insects are a highly nutritious and sustainable food source, offering numerous health benefits that position them as an attractive choice of alternative proteins. One of the most significant health advantages of edible insects is their high protein content. Insects such as crickets, grasshoppers and mealworms contain up to 50% protein by dryweight, providing all essential amino acids required by the human body. This makes them a complete protein source, comparable to or even surpassing traditional protein sources in terms of nutritional value.3,5 In addition to their high protein content, edible insects are also rich in essential micronutrients. They are particularly abundant in iron, zinc, magnesium, and B-vitamins, all of which are crucial for maintaining
good health.5 For instance, 100 grams of crickets provide up to 6.4mg of iron, significantly higher than other animal food sources.6 This makes insects an excellent dietary option for combating iron deficiency anaemia, a common nutritional disorder worldwide. Moreover, the fat content in edible insects is composed mainly of unsaturated fats, including omega-3 fatty acids, which are beneficial for cardiovascular health. The lipid profile of many insects closely resembles that of fish, promoting heart health by lowering cholesterol levels and reducing inflammation.
Insects also offer potential benefits for digestive health. They contain chitin, a type of dietary fibre that may act as a prebiotic, stimulating the growth of beneficial gut bacteria and enhancing gut health, supporting immune function and improving overall digestion. Additionally, edible insects are naturally low in carbohydrates, making them suitable for a wide range of diets, including those for individuals with gluten intolerance or other dietary restrictions.5 Overall, the consumption of edible insects provides a number of health benefits making them a valuable addition to the diet.
Importantly, insects can be raised on organic waste, contributing to a circular economy. Their high feed conversion efficiency makes them a sustainable protein source that will reduce the environmental impact of food production. As the global population continues to grow, edible insects offer a sustainable and nutritious solution to meet future food security challenges. Nevertheless, food security, impact of climate change on sustainable food production and food safety are one continuum and cannot be achieved independently.
Although insect proteins have shown positive health benefits, their possible allergenic status remains a key concern. As with any introduction

Professor Andreas Lopata and Dr Shay Karnaneedi analyse insect protein allergens in the laboratory. (Source: Molecular Allergy Research Lab, James Cook University)
of a new food source to the public, safety assessments are required which includes assessing for toxins, pathogens and particularly allergens. Allergenic proteins (allergens) causing food allergy, however, are more complex to detect and quantify as they are generally harmless proteins to the non-allergic consumer.
Evolutionarily, insects are closely related to crustaceans such as shrimps, crabs, and lobsters, as
they belong to the same phylum: Arthropoda. Therefore, many proteins from crustaceans and insects but also mites are similar through conserved protein regions and amino acid sequences. The mechanism of allergic hypersensitivity involves the recognition of serum immunoglobulin type E (IgE) antibodies to specific protein patches (epitopes) on an allergen. Due to the high similarity of certain proteins, these epitopes are similar in crustaceans and
insects.7 This increases the likelihood of IgE antibodies, which originally recognised a crustacean protein (allergen), to also bind to a similar allergen in insects and cause an allergic reaction; a phenomenon known as cross-reactivity in allergy.7,8
Given the high prevalence of crustacean food allergy in the general population (about 3%), this poses a significant threat to individuals already allergic to crustaceans also reacting upon consuming novel insect protein-based foods.
Studies have identified that one of the primary allergens in edible insects, particularly crickets, is tropomyosin, a muscle protein also found in crustaceans such as shrimp, crab, and lobster. This is likely the main protein responsible for the overall cross-reactivity observed between crustacean and insect allergies. Tropomyosin is highly heatstable and can therefore withstand heat treatment applied on foodgrade insect products to eliminate pathogens.9 Tropomyosin was found to be highly abundant in crickets.10 Individuals allergic to crustaceans may experience similar allergic reactions when consuming crickets, as the structure of tropomyosin is highly conserved across these species. Reactions can range from mild symptoms like itching, hives, or gastrointestinal discomfort to more severe responses, including anaphylaxis, which can be lifethreatening.
Aside from tropomyosin, several other proteins have been implicated as allergens including myosin light chain (muscle protein), arginine kinase (energy metabolism), troponin I (muscle protein), and hemocyanin (oxygen transport).10 Moreover, studies also demonstrate the presence of potential allergens unique to crickets including vitellogenin (yolk precursor), heat shock protein (stress protein), and apolipophorins (cellular messenger transport),10 indicating the need for more research to identify the diverse allergen profile of edible insect species. It is noted that
cross-reactivity between insects and molluscs (eg. mussels, snails, oysters) has not been reported and needs to be investigated further.
The identification of allergens in edible insect-based food products cannot be measured with the current testing methods as there are no insect-specific allergen test kits available. Despite the similarity of many allergens between edible insects and crustaceans, crustaceanspecific allergen test kits will not sufficiently detect allergens in insectbased foods.10 A recent collaborative study by James Cook University and the National Measurements Institute demonstrated a high variability of test results among different crustacean-specific allergen tests when used to detect allergens in edible cricket-based foods.10 This outcome recognises the need for the development of insect-specific food allergen tests to sufficiently detect cross-reactive and possible unique allergens in edible insects for accurate allergen labelling and for a safe consumer experience when consuming edible insects. While edible insects offer substantial nutritional benefits, their allergenic potential, particularly for individuals with crustacean allergies, cannot be overlooked. Careful management, labelling and consumer awareness are essential to ensure the safe integration of edible insects as alternative protein into the human diet, especially as they become more popular in global food markets. Allergen detection in insect-based food products or foods contaminated with edible insect allergens is crucial in ensuring food safety.
1. Santiago LA, Queiroz LS, Tavares GM, Feyissa AH, Silva NFN, Casanova F. (2024) Edible insect proteins: how can they be a driver for food innovation? Current Opinion in Food Science:101195.
2. FAO, Van Huis A, Van Itterbeeck J, Klunder H, Mertens E, Halloran A, Muir G, Vantomme P. (2013) Edible insects: future prospects for food and feed security: Food and Agriculture Organization of the United Nations.
3. Can Karaca A, Nickerson M, Caggia C, Randazzo CL, Balange AK, Carrillo C, Gallego M, Sharifi-Rad J, Kamiloglu S, Capanoglu E. (2023) Nutritional and Functional Properties of Novel Protein Sources. Food Reviews International;39(9):6045-77.
4. Fernandez-Cassi X, Supeanu A, Jansson A, Boqvist S, Vagsholm I. (2018) Novel foods: a risk profile for the house cricket (Acheta domesticus). EFSA Journal;16(S1):e16082.
5. Montowska M, Kowalczewski PŁ, Rybicka I, Fornal E. ( 2019) Nutritional value, protein and peptide composition of edible cricket powders. Food Chemistry;289:130-8.
6. Kosečková P, Zv ina O, P chová M, Krulíková M, Duborská E, Borkovcová M.(2022) Mineral profile of cricket powders, some edible insect species and their implication for gastronomy. Journal of Food Composition and Analysis;107:104340.
7. Kamath SD, Bublin M, Kitamura K, Matsui T, Ito K, Lopata AL. (2023) Cross-reactive epitopes and their role in food allergy. Journal of Allergy and Clinical Immunology;151(5):1178-90.
8. Lopata AL, Kleine-Tebbe J, Kamath SD. (2016) Allergens and molecular diagnostics of shellfish allergy. Allergo Journal International;25(7):210-8.
9. Ruethers T, Taki AC, Johnston EB, Nugraha R, Le TTK, Kalic T, McLean TR, Kamath SD, Lopata AL. (2018) Seafood allergy: A comprehensive review of fish and shellfish allergens. Mol Immunol.;100:28-57.
10. Karnaneedi S, Johnston EB, Bose U, Juhász A, Broadbent JA, Ruethers T, Jerry EM, Kamath SD, Limviphuvadh V, Stockwell S, Byrne K, Clarke D, Colgrave ML, Maurer-Stroh S, Lopata AL. (2024). The Allergen Profile of Two Edible Insect Species—Acheta domesticus and Hermetia illucens. Molecular Nutrition and Food Research. https://doi.org/10.1002/ mnfr.202300811
Funding: This research was funded by the 1st Singapore-Australia Bilateral Program on Innovations in Food for Precision Health, 2019 (Grant number: SG-AUS2019_191D4) encompassing a partnership between James Cook University, the Commonwealth Scientific and Industrial Research Organisation (CSIRO) and Singapore's Agency for Science, Technology and Research (A*STAR).
Professor Andreas L. Lopata is head of the Molecular Allergy Research Laboratory in the Australian Institute of Tropical Health and Medicine at James Cook University.
Dr Shaymaviswanathan Karnaneedi is a Lecturer at James Cook University supported by the Centre for Food Allergy Research, an NHMRC Centre of Excellence. f




The Turmeric range from Futurals and Natracol are made from pure, natural Curcumin and are available in water soluble, liquid and powder form each with a high heat tolerance. These attractive shades are suited for almost any food application, so if you are looking for colors that promote a healthy appetite, give us a call.
Applications: Bakery, Confectioneries, Beverages, Prepared Foods, Dairy and Pharmaceuticals.






Words by Dr Dan Dias, Dr Andrew Costanzo, Claudia Hartley and Simi Lewin

Detecting sugar syrup adulteration in UK honey using SORS and machine learning
Honey is widely consumed globally for its taste, nutritional value and perceived health benefits. However, the UK is not self-sufficient in honey production and was recently ranked among the top four honeyimporting countries worldwide and the 2nd largest importer in Europe. However, honey imports in Europe are projected to see limited growth in the coming years, largely due to consumer concerns regarding the purity and authenticity of honey.
In a recent study, researchers aimed to develop non-invasive sensor methods combined with multivariate data analysis to detect the type and percentage of exogenous sugar adulteration in UK honeys. They used through-container spatial offset Raman spectroscopy (SORS) on 17 different types of natural UK honeys collected over a season. These samples were then adulterated with rice and sugar beet syrups at concentrations of 10%, 20%, 30% and 50% w/w.
The data collected were used to build prediction models for 14 types of honey with similar Raman fingerprints, utilising different algorithms such as PLS-DA, XGBoost, and Random Forest, to detect the level of adulteration for each type of sugar syrup. Random Forest emerged as the best-performing algorithm,
with only 1% of pure honey samples misclassified as adulterated and less than 3.5% of adulterated samples misclassified as pure. Random Forest was further utilised to develop a classification model that successfully distinguished samples based on the type of adulterant (rice or sugar beet) and the level of adulteration. Additionally, SORS spectra were collected from 27 samples of heather honey produced in the UK, along with subsamples spiked with high fructose sugar cane syrup.
An exploratory data analysis using PCA and a classification with Random Forest both demonstrated clear separation between pure and adulterated samples at medium (40%) and high (60%) adulteration levels, with 90% accuracy even at low adulteration levels (20%).
Reference: Shehata M, et al. (2024) Application of Spatial Offset Raman Spectroscopy (SORS) and Machine Learning for Sugar Syrup Adulteration Detection in UK Honey, Foods 12, 2425. https:// doi.org/10.3390/foods13152425
Does health-related or tasterelated information influence consumer preference?
Consumers are increasingly concerned with the healthiness of food products without compromising on flavour. However, the way in which these attributes are communicated can impact consumer preferences. A recent study explored how the framing of health versus taste information influences both implicit and explicit liking of a
flavoured milk drink. The research provides valuable insights for food manufacturers on the nuances of product messaging and its effect on consumer behaviours.
The study presented participants with flavoured milk with different information on the product label. Participants were shown either health-related or taste-related information about the milk and then asked to evaluate it under two distinct liking measures: explicit (conscious) and implicit (subconscious). Explicit liking was measured using a standard liking scale, while implicit liking was assessed by measuring emotional and cognitive reactions in the brain using an electroencephalogram (EEG).
The results indicated a divergence between explicit and implicit responses. When snacks were framed with health-related information, participants showed higher explicit liking, likely due to the positive association with healthy eating. However, implicit liking was lower, suggesting that the subconscious preference for taste may dominate. Conversely, snacks framed with taste-related information were liked more implicitly but did not score as highly on explicit measures. These findings have important implications for food manufacturers. The research suggests that while health-related claims can boost conscious approval of a product, they
may not necessarily translate to an automatic preference. This highlights the challenge of balancing health and taste messaging in product labelling and marketing. For products aimed at health-conscious consumers, it may be beneficial to combine healthrelated information with taste cues to align both explicit and implicit liking. Moreover, understanding the split between conscious and subconscious preferences can help in designing more effective marketing strategies that cater to the complex nature of consumer decision-making.
Reference: Stickel, L., et al. (2024). Implicit and explicit liking of a snack with health-versus taste-related information. Food Quality and Preference, p.105293. https://doi.org/10.1016/j. foodqual.2024.105293
Consumer consumption behaviours and decision-making processes can be influenced by temperature. Previous research has established that temperature (ambient or product-related) can impact consumer perceptions and expectations of foods and beverages. Consumers perceive warm food to be more filling and tastier than cold food. However, little research has been conducted to investigate the impact of visual temperature cues on food photography.
A recent study from the University of Oxford conducted three online experimental studies where animated traces of steam and implied animation of steam (ie. a static picture of rising steam) were added to food images. Their research found that the animated steam increased the perceived temperature of the food product. Additionally, this increase in temperature perception led to an elevated perceived freshness and food desirability whereas implied animation did not have the same impact. Interestingly, the added animated steam successfully enhanced freshness perception and desirability for unappealing food images. The authors propose that for unappealing food images, there is potential to enhance palatability through the

addition of animated steam. This research highlights the importance of temperature perception in food appreciation. Moreover, it demonstrates the effectiveness of using animated steam as a visual cue to enhance food desirability and temperature perception, highlighting its potential in food marketing, advertising and digital food creation. The authors suggest that future research in the area should incorporate new variables such as the context of consumption and cultural differences in food perception.
Reference: Zhang, T., et al. (2024). ‘Hot stuff’: Making food more desirable with animated temperature cues. Food Quality and Preference, 120:105233, https://doi.org/https://doi. org/10.1016/j.foodqual.2024.105233
A study aimed to determine if individuals can distinguish AIgenerated from real food images, how food processing levels impact this ability and whether disclosing the image's source influences its appeal. The research involved two online experiments using images of food that ranged from unprocessed, processed and ultra-processed. In one arm of the study, participants were shown both a real food image and its AI-generated version sideby-side and asked to identify which one was AI-generated. They were then shown one image at a time, either real or AI-generated, and asked whether the image was real or AI-made. Participants then looked at individual food images and rated
their confidence in whether the image was real or AI-generated on a scale from "Definitely AI-generated" to "Definitely Real." The results showed that participants were particularly good at recognising AI-generated images of ultra-processed foods, but there was no significant difference in their ability to identify AI images of unprocessed and processed foods, with older participants being less accurate overall.
The second part of the study found that AI-generated food images looked more appetising when their source was unknown. However, when labelled correctly, there was no significant difference in appeal between real and AI images except for ultra-processed foods, which were found to be more appetising in their real forms. Mislabelled AI images were rated as more appealing when participants thought they were real. Overall, while AI images initially seem more attractive, their appeal decreases when their AI origin is revealed. These findings offer insights into how consumers view food in a world where AI is increasingly used in marketing, highlighting how technology can subtly shape preference and perception.
Reference: Califano, G. & Spence, C. (2024). Assessing the visual appeal of real/AIgenerated food images. Food Quality and Preference, 116, 105149. https://doi.org/10.1016/j. foodqual.2024.105149
Dr Dan Dias is Senior Lecturer, Dr Andrew Costanzo is Lecturer, Claudia Hartley is a PhD student and Simi Lewin is Research Manager. All are at CASS Food Research Centre at Deakin University. f
can we do better on the food market?

Words by Brittany Harriden, Dr Costas Stathopoulos and Dr Nenad Naumovski
Incorporating Australian native plants into modern diets and revitalising Indigenous food practices can improve health outcomes and increase sustainability. Rediscovering Australian native foods and traditional methods is a strategy that can contribute to tackling climate change, and chronic diseases such as cardiovascular disease, type II diabetes mellitus and Alzheimer’s disease. Globally and in Australia, Indigenous communities have long utilised sustainable food practices (from farming to food consumption), deeply linking their food to history, identity and the environment in a way that is integral to their holistic wellbeing.1 Recent research highlights the nutritional benefits of Australian native plants, their resilience to environmental stress, and their role in fostering sustainable food systems due to their high nutrient and phytochemical content.2-4 Despite increasing international interest in Australian native plants, research and utilisation of these food products
in Australia remains relatively unexplored.
Currently, Australian native foods such as Kakadu plum (Terminalia ferdinandiana), Finger lime (Citrus australasica) and Davidson plum (Davidsonia pruriens) are being incorporated into the Western diet and utilised in highly processed foods such as crisps, cakes, jams and jellies, ice-cream.5 There is a significant controversy in the current literature on the topic of ultra-processed foods (UPFs). This is predominantly due to their ‘loose’ definition as formulations of industrial ingredients that result from a series of industrial processes and are either pre-cooked or can be quickly heated, often containing minimal amounts of whole foods.6 This category encompasses a wide range of items such as soft drinks, pre-packaged snacks, sweetened breakfast cereals, cookies, processed meats and ready-made meals that are either frozen or have a long shelf
life.6 There are a number of reasons why foods need to be processed, such as preservation of key nutrients, extension of shelf life, food safety, food quality and improvements in taste and texture.6 This processing is crucial for meeting dietary needs by offering safe and stable foods and enhancing nutritional, functional and sensory qualities. Processed foods also provide convenience, variety in the diet, shorter preparation times, increased availability during offseasons or poor weather conditions, and can ensure a consistent supply to remote areas. However, UPFs are generally formulated to be palatable or hyper-palatable, which may counteract the importance of processing from a health perspective as the selection of additives used may be harmful to human health.7
Integration of Australian native food products into current dietary
practices in Australia can offer nutritional, environmental and cultural benefits.8 Some Australian native plants have been used by Indigenous people for thousands of years for their nutritional and medicinal properties, examples include the Macadamia nut (Macadamia integrifolia), Lemon Myrtle (Backhousia citriodora) and Wattleseed (Acacia victoriae). Although the Western-style dietary pattern is predominant in Australia, Indigenous native plants can provide tremendous opportunities to provide dietary diversification, support local ecosystems and reduce the environmental impact of food production. It is a step towards a more sustainable and healthier way of eating. Few Indigenous fruits have been exploited in Australia with only a limited number being researched for commercial use. There are several factors as to why this may be the case, including ethical implications to industrialise Australian native plants, cultivation challenges, economic viability, and lack of awareness and promotion of the benefits and uses of Australian native plants among consumers and industry. These factors combined contribute to the slower commercialisation of Australian native plants. Many Australian native plants are selected because of the traditional knowledge of Indigenous communities. The cultural and practical significance of these plants is linked to their heritage and cultural identity, however some of this knowledge has not been carried down from the Elders. The industry development of native plants requires Aboriginal stakeholders to be involved in the process,9 in addition knowledge of these plants is restricted to certain tribes therefore approval from the traditional owners must be granted. Many traditional
landowners have obligations to care for their country, which includes proper harvesting practices and protocols to minimise tree cutting and prevent waste. Although Australia has hundreds of edible native plants, current research has only focused on 14 commercially available fruits, emphasising propagation, breeding, cultivation, nutritional value and the isolation of natural products. However, none of these fruits have been researched comprehensively in all these areas.10
Exotic plants often have established markets and proven profitability therefore investing in native plants
R+K_AD_2024_118x162 Food_Australia.qxp_Layout 1 29.04.24 07:43 Seite 2
carries more risk and uncertain returns, making them less attractive to commercial growers, particularly when research and development for native plants is limited resulting in fewer varieties being optimised for commercial production. Moreover, improving genotypes for native plants is necessary for large-scale production however this has not yet been considered. While native plants have commercial potential for farmers, many species are becoming endangered due to land clearing and degradation, necessitating conservation efforts. Additionally, many Australian native plants are

New product ideas need new colours. Mix and match the winning colour for your next product from the ERKA palette on our website.






seasonal and primarily found in Northern Australia (Queensland and Northern Territory), making wild harvesting costly due to seasonal variability, harvesting periods, transport and labour costs.10 Furthermore, many native plants have specific growing conditions and are difficult to cultivate on a large scale as they require unique soil types, climates, or maintenance that isn't easily replicated in commercial settings. Australian native plants are currently underutilised in Western diets, however, they contain a significant amount of antioxidants and phytochemicals, which enhances their importance for dietary strategies aimed at promoting health and reducing the incidence of chronic disease.11 Collaborating with Indigenous communities will help preserve native plant species that are at risk due to climate change, habitat destruction and other environmental threats. Australian Indigenous knowledge can guide the identification, protection and restoration of vital ecosystems. Furthermore, learning from Indigenous practices of cultivating native plants may provide more sustainable
agricultural methods and practices that are often more in harmony with local ecosystems and can improve food security and diversity.12, 13
Future directions should focus on engagement with Indigenous communities to utilise native plants. This is crucial to ensuring that they lead and benefit from the research whilst building partnerships based on mutual respect. In addition, utilising Australian native plants presents several promising future directions with some key foci including sustainability, conservation and most importantly cultural preservation.14 Therefore, collaborating on projects that document and preserve Indigenous knowledge of native plants helps maintain cultural heritage and biodiversity while raising awareness about the importance of native plants, traditions and potential medicinal benefits.
1. B. Porykali, A. Davies, C. Brooks, H. Melville, M. Allman-Farinelli and J. Coombes, Effects of Nutritional Interventions on Cardiovascular Disease Health Outcomes in Aboriginal and Torres Strait Islander Australians: A Scoping Review, Nutrients, 2021, 13.
2. C. V. A. Lopes, S. Mihrshahi, R. Ronto and J. Hunter, Aboriginal Food Practices and Australian Native Plant-Based Foods: A Step toward Sustainable Food Systems, Sustainability, 2023, 15, 11569.
3. I. H. Dissanayake, V. Zak, K. Kaur, K. Jaye, Z. Ayati, D. Chang, C. G. Li and D. J. Bhuyan, Australian native fruits and vegetables: Chemical composition, nutritional profile, bioactivity and potential valorization by industries, Critical reviews in food science and nutrition, 2022, DOI: 10.1080/10408398.2022.2057913, 1-34.
4. R. Richmond, M. Bowyer and Q. Vuong, Australian native fruits: Potential uses as functional food ingredients, JOURNAL OF FUNCTIONAL FOODS, 2019, 62.
5. L. Smith, Bush Foods - An Aussie Culinary Experience, https://npq.org.au/article-bushfoods-an-aussie-culinary-experiance/.
6. L. Elizabeth, P. Machado, M. Zinöcker, P. Baker and M. Lawrence, Ultra-Processed Foods and Health Outcomes: A Narrative Review, Nutrients 2020, 12, 1955.
7. L. G. Baraldi, G. Cannon, G. Cediel, P. C. Jaime, N. Khandpur, R. B. Levy, M. L. C. Louzada, E. Martinez-Steele, C. A. Monteiro, J.-C. Moubarac, D. Neri and F. Rauber, Ultra-processed foods: what they are and how to identify them, Public Health Nutrition, 2019, 22, 936-941.
8. V. J. Clemente-Suárez, A. I. Beltrán-Velasco, L. Redondo-Flórez, A. Martín-Rodríguez and J. F. Tornero-Aguilera, Global Impacts of Western Diet and Its Effects on Metabolism and Health: A Narrative Review, Nutrients, 2023, 15.
9. T. Hay, S. Prakash, V. D. Daygon and M. Fitzgerald, Review of edible Australian flora for colour and flavour additives: Appraisal of suitability and ethicality for bushfoods as natural additives to facilitate new industry growth, Trends in Food Science & Technology, 2022, 129, 74-87.
10. A. K. Ahmed and K. A. Johnson, Horticultural development of Australian native edible plants, Australian Journal of Botany, 2000, 48, 417-426.
11. Y. Sultanbawa, Australian Native Plant Foods and Their Contribution to Diet Diversity, Proceedings 2019, 36, 111.
12. L. Joseph and N. J. Turner, “The Old Foods Are the New Foods!”: Erosion and Revitalization of Indigenous Food Systems in Northwestern North America, Frontiers in Sustainable Food Systems, 2020, 4.
13. M. Ferguson, C. Brown, C. Georga, E. Miles, A. Wilson and J. Brimblecombe, Traditional food availability and consumption in remote Aboriginal communities in the Northern Territory, Australia, Australian and New Zealand Journal of Public Health, 2017, 41, 294-298.
14. E. J. Ens, M. Finlayson, K. Preuss, S. Jackson and S. Holcombe, Australian approaches for managing ‘country’ using Indigenous and nonIndigenous knowledge, Ecological Management & Restoration, 2012, 13, 100-107.
Ms Brittany Harriden is a PhD candidate in Food Science and Human Nutrition in the Discipline of Nutrition and Dietetics at the University of Canberra, ACT, Australia.
Dr Costas Stathopoulos is a Professor of Food Science at the Food Futures Institute at Murdoch University, Nambeelup, WA, Australia.
Dr Nenad Naumovski is a Professor of Food Science and Human Nutrition in the Discipline of Nutrition and Dietetics at the University of Canberra, ACT, Australia. f

Food testing

Enhance your pathogen detection using the SureTect Automation Workflow for the ultimate in lab efficiency
In your pursuit of food safety and quality, time and accuracy are of the essence. For reliable and rapid detection of food pathogens and spoilage organisms, the Thermo Scientific™ SureTect™ PCR System delivers robust, consistent results faster than traditional reference methods. Now, with the Thermo Scientific™ SureTect™ Automation Workflow, you can take your testing to the next level with automated lysis and PCR setup. Utilizing the CyBio™ FeliX Instrument, the automated workflow allows you to reduce handson time whilst increasing the accuracy of your testing, enabling technicians to focus on other tasks.
Rapid set-up and walk-away automation minimizes hands-on time in your workflow.
Precise pipetting reduces the risk of human error and cross-contamination, improving the reproducibility of results.
Manage up to 6 assays and up to 96 samples in a single run, with the choice to automate lysis, PCR setup or both.

A recent protein roadmap report by CSIRO indicates that by 2050, the global population is projected to increase to about 9.7 billion, thus presenting a significant challenge in terms of food supply.1,2 Proteins from animal and plant sources, being an essential part of human nutrition, will be in high demand. Australia’s plantbased protein sector is relatively modest in comparison to other nations, considering the sustainable aspects and changes in human dietary pattern. The sector is on an upward trajectory, with projected investment of around $6 billion by 2030 in plant-based proteins.1
The increase in investments for functional foods and plant proteins has indirectly propelled seaweed production worldwide, with a more than 10% rise in seaweed-infused food products between 2020-2021 alone.3 According to the Australian Seaweed industry blueprint,4 the sector represents a sustainable and lucrative economic prospect for Australia that can lead to enhanced marine ecosystem health, employment creation in coastal regions and high-value goods for local and international markets, while contributing significantly to reducing Australia’s carbon footprint. Despite its vast marine resources, historical usage, and profound maritime ties, Australia has been slow to capitalise on the potential of seaweed production.5
Plant proteins are usually lacking in functionality, primarily in terms of solubility, emulsifying ability, and bioactive potentials, compared to those from animal sources.6
To overcome these limitations, different methodologies have been developed over the years, including pulsed electric fields, high pressure and enzymatic processing.6,7,8 The limitations with these methods typically come from the use of solvents or excessive processing that might lead to unwanted changes in the proteins. Moreover, several of these methods are yet to be scaled for manufacturing. Australia has an opportunity to benefit from enhancing the right infrastructure and technology to upscale the processing of plant-based proteins.
Maillard conjugation is a technique that is a part of a complex process called Maillard reaction. The Maillard reaction is the one that turns bread brown when toasted.9 Maillard conjugation harnesses the initial stage of Maillard reaction to improve plant protein properties by attaching amino acids (the building blocks of proteins) to sugars, which helps to improve the qualities and functions of the protein conjugates.6
However, the conventional methods of conjugation such as wet
or dry-state methods are lab-based and targeted towards small scale trials with several drawbacks. The properties of conjugates produced by such methods can be unpredictable due to low conjugation efficiency, slow rate of glycation, sensitivity to changes in the environment such as humidity, and the process can sometimes lead to unwanted byproducts. Moreover, these methods often involve freeze-drying to control the reactions from advancing further, which can be resource extensive, especially at industrial scale.10
To overcome these challenges, new techniques including microwave and high-pressure processing assisted conjugations have been explored.11,12 Ultrasonication, which uses highfrequency sound waves (outside the range of human hearing) to enable rapid conjugation, has shown promising results, especially when used with plant-based proteins.13,14,15 However, earlier research focused on the use of simplified models, which means most of the findings were based on the utilisation of one or two isolated ingredients. This does not reflect the complexity of real-world food systems and industrial applications, where different ingredients often interact with each other. Thus our research aimed to improve the process of Maillard conjugation using complex ingredients, to produce enhanced plant proteins more reliably. These conjugated proteins can then be turned into powders, and could
potentially be used as functional ingredients in various food products.
Seaweeds are rich in various polysaccharides and thus can be an excellent resource for Maillard conjugation with plant proteins, providing the necessary sugar units to react with amino acids. Seaweed also offers a wealth of minerals, vitamins, and dietary fibres and are a great source of bioactive compounds due to their abundant phytochemicals.16 The Gracilaria genus, as part of the Rhodophyta division (red algal seaweed), is notably plentiful along the Australian coast.17 These red seaweeds boast a variety of phyto-components, including polyphenols, alkaloids, halogenated compounds, and polysaccharides such as agar, carrageenan, proteoglycans, alginate, laminaran, fucoidan, as well as carotenoids, terpenoids, xanthophylls, vitamins, and a range of fatty acids, both saturated and polyunsaturated.16 Leveraging these edible seaweeds with plant protein could pave a way for commercial ventures by value-adding this abundant commodity. Overall, it is crucial to find a practical way to modify plant proteins and seaweeds to make them more useful. We demonstrated that red seaweeds can be utilised in their entirety to improve plant proteins via Maillard conjugation.
Considering the vast number of parameters that can be used to create such conjugates, it was essential to find a way to reduce these parameters. This was achieved by creating a neural network (part of machine learning) that assisted in reducing the number and range of parameters, thus using less time and resources for the experimental trials (Figure 1). The parameters were first tested on a model system (using only seaweed polysaccharide and amaranth protein) (Figure 2). The initial findings

Figure 1: Overall process schematic of conjugation between seaweed and plant protein using a neural network model to reduce the variation of parameters for optimised experimental design.

Figure 2: Raw ingredients as inputs for Maillard conjugation resulting in seaweed-plant protein conjugates and Maillard reaction products obtained via spray drying.
indicated that the estimated range of parameters could produce these conjugates more effectively. We also demonstrated that spraydrying is a quicker and easier method to make conjugate powders without sacrificing too much of the functionality of the final products, compared to the freeze-drying method.10
The approach was further tested on more complex systems by directly mixing dried red seaweed (Gracilaria secundata) with amaranth seed protein (Figure 2). The study focused on investigating how the structure and chemistry of seaweed and protein changed, while targeting the changes in antioxidants in the mixture. It was found that the combined conjugates and intermediate products were robust enough to withstand conjugation and spray drying processes, creating various intermediates during the treatment. The loss of overall antioxidants was reduced through a shielding effect when entire seaweed was utilised, which was attributed to components released from seaweeds and the reaction products. The study demonstrated the efficacy of the process, showing that the approach could be used on complex systems such as whole seaweeds, instead of only the extracted polysaccharides.18
Both the model and the complex protein-seaweed systems showed higher solubility, emulsification capacity, and foamability, compared to the amaranth protein alone, and increased antioxidant potentials as confirmed by antioxidant assays including DPPH and CUPRAC. A variety of heat-labile plant and seaweed elements were also detected in the final powders, indicating the shielding effects of the systems over these components. Maillard conjugates and Maillard reaction products are complex components, and thus it is crucial to understand how they are digested. The findings from an in vitro digestion study suggested that these compounds can release antioxidants and other components

3: Chord Diagram highlighting various key components produced during Maillard conjugation that can potentially be used for targeted delivery or isolated for further use. The corresponding numbers show the amounts of different components detected in each of the samples (conjugates, Amaranth and seaweed Gracilaria). (adapted from Naik et al.19 with permission under creative commons attribution license (CC BY)).
more effectively in a dialysis-based absorption test.19 The antioxidants and amino acids were not digested in the stomach phase of digestion but were broken down in the intestinal phase. This indicates that the amino acids were released slowly during digestion, and potentially the use of these compounds could be explored to improve the uptake of dietary antioxidants. However, real human digestion is influenced by many factors and is much more complicated to fully simulate. Therefore, more advanced studies pertaining to dietary clinical trials are recommended.
There are other plant-based proteins, such as those from buckwheat, mung bean, rapeseed, quinoa and amaranth seed protein, which are nutritionally superior and less likely to cause allergies compared to popular commercial plant proteins such as soy and gluten.20,21,22 The process of creating plant protein conjugates results in a variety of reaction products (Figure 3). These products have a wide range
of uses and can be incorporated into different industries, including those that produce supplements or functional foods. These intermediates include potent bioactive components that are a part of algal or plant ingredients, or the results of the intermediate reactions during the Maillard process, producing different flavours or antioxidant components. To understand the range of potential outcomes from Maillard conjugation under different conditions, approaches such as molecular docking studies, combined with machine learning can be used to conduct detailed investigations at the molecular level.
A key application of plant protein conjugates can be as carriers for bioactive ingredients.19,23 Further research can focus on the use of these blends as emulsifiers or stabilisers in food24,25 or to improve properties such as foaming or whipping. They may offer potential health benefits by boosting antioxidant activity and promoting gut health.19,26 There are wide-ranging applications of Maillard conjugates, however, more investigation is

needed to explore their production and applications in industrial settings, especially in the development of innovative and functional food solutions.
1. CSIRO. (2023) Australia's Protein Roadmap CSIRO. https://www.csiro.au/en/work-withus/services/consultancy-strategic-adviceservices/CSIRO-futures/Agriculture-and-Food/ Australias-Protein-Roadmap
2. United Nations Department of Economic and Social Affairs, (2022) World Population Prospects 2022: Summary of Results. https:// www.un.org/development/desa/pd/sites/www. un.org.development.desa.pd/files/wpp2022_ summary_of_results.pdf
3. Fortune Business Insights, F. B. I. (2021) Commercial Seaweed Market Size, Growth, Share & Forecast 2027. Retrieved 05-March from https://www.fortunebusinessinsights. com/industry-reports/commercial-seaweedmarket-100077
4. Kelly, J. (2020) Australian seaweed industry blueprint-a blueprint for growth
5. Roos, G., Cheshire, A., Nayar, S., Clarke, S. M., & Zhang, W. (2018) Harnessing Marine Macroalgae for Industrial Purposes in an Australian Context: Emerging Research and Opportunities:
6. Naik, R. R., Wang, Y., & Selomulya, C. (2021) Improvements of plant protein functionalities by Maillard conjugation and Maillard reaction products. Critical Reviews in Food Science and Nutrition, 1-26. https://doi.org/10.1080/1040839 8.2021.1910139
7. Kim, W., Wang, Y., & Selomulya, C. (2020) Dairy and plant proteins as natural food emulsifiers. Trends in Food Science & Technology, 105, 261272. https://doi.org/10.1016/j.tifs.2020.09.012
8. Wang, Y., Kim, W., Naik, R. R., & Selomulya, C. (2023) Functionality of plant-based proteins in Engineering Plant-Based Food Systems (pp. 79-96). Elsevier.
9. Nursten, H. (2005) The Chemistry of Nonenzymic Browning. in The Maillard Reaction: Chemistry, Biochemistry and Implications (pp. 5-30). The Royal Society of Chemistry. https:// doi.org/10.1039/9781847552570-00005
10. Naik, R. R., Wang, Y., & Selomulya, C. (2022) Spray-drying to improve the functionality of amaranth protein via ultrasonic-assisted Maillard conjugation with red seaweed polysaccharide. Journal of Cereal Science, 108, 103578. https:// doi.org/10.1016/j.jcs.2022.103578
11. Nooshkam, M., & Madadlou, A. (2016) Microwave-assisted isomerisation of lactose to lactulose and Maillard conjugation of lactulose and lactose with whey proteins and peptides. Food Chemistry, 200, 1-9. https://doi. org/10.1016/j.foodchem.2015.12.094
12. Sedaghat Doost, et al. (2019) Maillard conjugation as an approach to improve whey proteins functionality: A review of conventional and novel preparation techniques. Trends in Food Science & Technology, 91, 1-11. https://doi. org/10.1016/j.tifs.2019.06.011
13. de Oliveira, A. P. H. et al. (2020) Combined adjustment of pH and ultrasound treatments modify techno-functionalities of pea protein concentrates. Colloids and Surfaces A: Physicochemical and Engineering Aspects 603, 125156. https://doi.org/10.1016/j. colsurfa.2020.125156
14. Jarzebski, M. et al. (2019) Pea protein for hempseed oil nanoemulsion stabilization. Molecules, 24(23). https://doi.org/10.3390/ molecules24234288
15. Rahman, M. M., & Lamsal, B. P. (2021) Ultrasound-assisted extraction and modification of plant-based proteins: Impact on physicochemical, functional, and nutritional properties. Comprehensive Reviews in Food Science and Food Safety, 20(2), 1457-1480. https://doi.org/10.1111/1541-4337.12709
16. de Almeida, C. L. F.et al (2011) Bioactivities from marine algae of the genus Gracilaria. International Journal of Molecular Sciences 12(7), 4550-4573. https://doi.org/10.3390/ ijms12074550
17. Byrne, K., Zuccarello, G. C., West, J., Liao, M. L., & Kraft, G. T. (2002) Gracilaria species (Gracilariaceae, Rhodophyta) from southeastern Australia, including a new species, Gracilaria perplexa sp. nov.: morphology, molecular relationships and agar content. Phycological research, 50(4), 295-311.
18. Naik, R. R., Ye, Q., Wang, Y., & Selomulya, C. (2024a) Assessing the effect of Maillard reaction products on the functionality and antioxidant properties of Amaranth-red seaweed blends. Food Research International, 175, 113759. https://doi.org/10.1016/j.foodres.2023.113759
19. Naik, R. R., Ye, Q., Wang, Y., & Selomulya, C. (2024b) Insights into multi-component digestion and antioxidant release from plant protein-seaweed-based Maillard conjugate-MRP systems. Future Foods, 100380.
20. Constantino, A. B. T., & Garcia-Rojas, E. E. (2022) Proteins from pseudocereal seeds: solubility, extraction, and modifications of the physicochemical and techno-functional properties. Journal of the Science of Food and
Agriculture, 102(7), 2630-2639. https://doi. org/10.1002/jsfa.11750
21. Henrion, M., Labat, E., & Lamothe, L. (2020) Pseudocereals as healthy grains. In Innovative Processing Technologies for Healthy Grains (pp. 37-59). https://doi.org/10.1002/9781119470182. ch3
22. Martínez-Villaluenga, C., Peñas, E., & HernándezLedesma, B. (2020) Pseudocereal grains: Nutritional value, health benefits and current applications for the development of gluten-free foods. Food and Chemical Toxicology, 137, 111178. https://doi.org/10.1016/j.fct.2020.111178
23. Nooshkam, M., & Varidi, M. (2020) Maillard conjugate-based delivery systems for the encapsulation, protection, and controlled release of nutraceuticals and food bioactive ingredients: A review. Food Hydrocolloids, 100, 105389. https://doi.org/10.1016/j.foodhyd.2019.105389
24. Caballero, S., & Davidov-Pardo, G. (2021) Comparison of legume and dairy proteins for the impact of Maillard conjugation on nanoemulsion formation, stability, and lutein color retention. Food Chemistry, 338, 128083. https://doi.org/10.1016/j.foodchem.2020.128083
25. Zhao, Huang, Y., McClements, D. J., Liu, X., Wang, P., & Liu, F. (2022) Improving pea protein functionality by combining highpressure homogenization with an ultrasoundassisted Maillard reaction. Food Hydrocolloids 126, 107441. https://doi.org/10.1016/j. foodhyd.2021.107441
26. Mao, L., Pan, Q., Hou, Z., Yuan, F., & Gao, Y. (2018) Development of soy protein isolatecarrageenan conjugates through Maillard reaction for the microencapsulation of Bifidobacterium longum. Food Hydrocolloids, 84, 489-497. https://doi.org/10.1016/j. foodhyd.2018.06.037
Dr Rishi Ravindra Naik is a Postdoctoral Research Associate in Food Science and Technology at the School of Chemical Engineering, UNSW Sydney.
Dr Yong Wang is a Senior Lecturer at the School of Chemical Engineering, UNSW Sydney.
Dr Cordelia Selomulya holds the position of Professor and Associate Dean of Research at UNSW Sydney. f

Words by Dr Heather Smyth and Dr Rebecca Forster
The proliferation of plant-based meat products in supermarkets worldwide reflects growing consumer interest in alternative protein sources. Consumers want to reduce their red meat consumption for environmental, ethical, health and religious reasons.1 To maintain the sensory experience for consumers who want to eat less meat, plantbased meat alternatives aim to mimic the sensory properties of animalbased meat products. However, replicating the appearance, aromas, flavours and textures of meat remains challenging. Industry reports concur consumer uptake has slowed because of price, taste and texture disparities between meat and meat analogues.2,3 As the world faces a projected shortage of protein-rich foods, plantbased meats are expected to become a major source of dietary protein and as such, it is vital to improve the eating experience of meat analogues.4
In a recently published study, we reported a detailed comparison of the sensory properties of commercially available animal and plant-based burgers.5 By evaluating eight animalbased burgers and 11 high protein plant-based burgers, the study aimed to identify key differences in aroma, flavour, texture and aftertaste that may affect consumer acceptability. A secondary objective of this study was to determine the sensory “gaps” between animal and plantbased burgers that could inform the development of improved plantbased meat products. A diverse selection of commercially available burger samples (Figure 1) was assessed:
Animal-based burgers: Included beef (fresh and frozen, thick and thin, high and low gristle content), chicken, kangaroo, pork and turkey burgers. Plant-based burgers: Included highprotein options with greater than 13
grams of protein per 100 grams of burger mixture, namely Alternative, Beyond, Earth Grown, Eaty, Fry’s, Gardein, Linda McCartney’s, Moving Mountains, Naturli’, v2, and Veef. Notable exclusions were vegetable patties that did not aim to mimic meat products and Impossible Burger, which was not available in Australia during the study period. The study employed a trained sensory panel of 14 experienced tasters to assess the sensory properties of the burgers using conventional descriptive analysis. Thirty-two sensory attributes were defined to describe the samples during oral processing, from the initial bite through to bolus formation and swallowing. The study’s novelty was its use of a trained panel and a comprehensive approach, compared to previous research that relied on untrained consumer panels or limited sensory attributes.6,7

Figure 2: Cobweb plots showing the average scores for aroma attributes (a) or flavour attributes including flavour-related aftertaste attributes (b) of 8 animal (red) and 11 plant-based (green) burgers (n = 14 panellists x 4 repetitions).
Aroma: The sensory panel perceived distinct differences in aroma between animal and plant-based burgers. The animal-based burgers scored high for meaty aroma (Figure 2a). Animal-based samples also received low scores for legume and vegetative aroma attributes, except for chicken which had a strong vegetative aroma of “green vegetable, capsicum, grassy, or fresh herbal notes” (Figure 2a). Conversely, the plant-based burgers scored higher for legume aroma (Figure 2a). Plant-based samples clustered into two main aroma profiles: one group received higher scores for a caramelised aroma with “sweet notes such as carrot, sweet potato, or caramelised onion”, and the other group scored higher for sharp, smoky, spicy herbal, or vegetative aroma attributes. The formation of two clusters reflects the two main flavour selections made by product developers attempting to recreate the complex meaty aroma in commercial plant-based meat formulations. However, neither flavour system was successful in creating a convincing meaty note that was close to the meatiness of animal-based burgers (Figure 2a).
Flavour: Flavour profiles also differed markedly between animal and plant-based burgers. The animal-based burgers generally received higher scores for flavour intensity, lingering flavour, meaty, saltiness, sweetness, and umami flavour attributes (Figure 2b). Animal-based samples also scored low for bitterness and lingering spice flavour attributes (Figure 2b). In contrast, the

Figure 3: Scales showing the average scores for texture attributes including texture-related aftertaste attributes of 8 animal (red) and 11 plant-based (green) burgers (n = 14 panellists x 4 repetitions).
flavour profiles of the plant-based burgers were more diverse between brands. Several plant-based samples scored higher for bitterness and lingering spice flavour attributes while others were characterised by their sour or sweet taste (Figure 2b). The broader flavour spectrum of plant-based burgers indicates the ongoing challenge of achieving meaty and umami flavoured meat analogues. Texture: Texture emerged as a significant differentiator between animal and plant-based burgers. The animalbased burgers generally scored high for juiciness, fattiness, and final moistness attributes, except for kangaroo which received lower scores for juiciness and fattiness (Figure 3). Animal-based samples also generally scored lower for the attribute cohesiveness (Figure 3). Previous sensory evaluation of meat analogues has reported on the importance of three texture attributes: juiciness, tenderness, and fibrousness.8,9 However, this study identified seven key dimensions in the sensory space, expanding our understanding of meat-like textures. These dimensions include:
1. Density: Related to the density of the sample
2. Firmness: Associated with firmness, chewiness, and elasticity attributes
3. Disintegrating: Related to how easily the sample falls apart
4. Juiciness: Associated with juiciness, fattiness, and final moistness attributes
5. Coarseness: Associated with coarseness, cohesiveness, and gristly attributes
6. Residual: Associated with bitsiness and clearance attributes
7. Crust: Related to the presence of a distinct crust. Interestingly, while juiciness and firmness (equivalent to tenderness) are key dimensions, fibrousness was not an important attribute in the sensory evaluation of animal and plant-based burgers. This suggests that fibrousness may be more relevant to whole muscle cuts such as steak rather than ground burgers, although it remains

an important area of research for improving plant-based textures.10 These seven sensory dimensions offer a broader framework for future product development and research, aiming to close the gap between meat and meat analogues.
In this study, we compared the sensory properties of commercially available animal and plant-based burgers. Our comprehensive evaluation of 19 samples identified the key sensory differences and areas for improvement in plant-based burgers to enhance consumer acceptability. The study’s findings provide valuable insights into the sensory attributes and dimensions that should guide the development of future plant-based meat products. As the food industry strives towards developing more plant-based protein alternatives, it is essential that we consider and retain enjoyable sensory experiences. Ultimately, if food doesn’t taste good, consumers won’t continue to buy it, regardless of any perceived sustainability or health benefit.

1. He, J., Evans, N. M., Liu, H., & Shao, S. (2020). A review of research on plant-based meat alternatives: Driving forces, history, manufacturing, and consumer attitudes. Comprehensive Reviews in Food Science and Food Safety, 19(5), 2639-2656. https://doi. org/10.1111/1541-4337.12610
2. Battle, M., Pierce, B., Carter, M., Colley Clarke, J., Fathman, L., Gertner, D., Ignaszewski, E., Mansukhani Kogar, N., Leet-Otley, T., & Panescu, P. (2024). 2023 State of the Industry Report: Plant-based meat, seafood, eggs, and dairy. The Good Food Institute. https://gfi.org/wp-content/ uploads/2024/05/2023-State-of-the-industryreport_Plant-based.pdf
3. Kalocsay, K., Eassom, S., O’Neill, S., Cogo, K., & Redmond, M. (2024). State of the Industry: Australia’s plant-based meat industry. Food Frontier. https://www.foodfrontier.org// wp-content/uploads/dlm_uploads/2024/04/ FoodFrontier-2023-State-of-the-Industry-report. pdf
4. United Nations, Department of Economic and Social Affairs, Population Division (2019). World Population Prospects 2019: Highlights. https:// population.un.org/wpp/publications/files/ wpp2019_highlights.pdf
5. Forster, R. A., Hassall, E., Hoffman, L. C., Baier, S. K., Stokes, J. R., & Smyth, H. E. (2024). Comparing the sensory properties of commercially available animal and plant-based burgers. Journal of Texture Studies, 55(3). https://doi.org/10.1111/jtxs.12838
6. Cuthbertson, H., Polkinghorne, R., Tarr, G., & Watson, R. (2020). Baseline consumer sensory testing of alternate protein burgers. Meat and Livestock Australia Limited. https://www.mla. com.au/globalassets/mla-corporate/researchand-development/final-reports/2021/v.rmh.0111final-report.pdf
7. Godschalk-Broers, L., Sala, G., & Scholten, E. (2022). Meat Analogues: Relating Structure to Texture and Sensory Perception. Foods, 11, 2227. https://doi.org/10.3390/foods11152227
8. Fiorentini, M., Kinchla, A. J., & Nolden, A. A. (2020). Role of Sensory Evaluation in Consumer Acceptance of Plant-Based Meat Analogs and Meat Extenders: A Scoping Review. Foods, 9, 1334. https://doi.org/10.3390/foods9091334
9. Ilic, J., Djekic, I., Tomasevic, I., Oosterlinck, F., & van den Berg, M. A. (2022). Materials Properties, Oral Processing, and Sensory Analysis of Eating Meat and Meat Analogs. Annual Review of Food Science and Technology, 13, 193. https://doi. org/10.1146/annurev-food-090821-032332
10. Dekkers, B. L., Boom, R. M., & van der Goot, A. J. (2018). Structuring processes for meat analogues. Trends in Food Science & Technology 81, 25. https://doi.org/10.1016/j.tifs.2018.08.011
Professor Heather Smyth is the Deputy Director of Research at the Queensland Alliance for Agriculture and Food Innovation and a Professorial Research Fellow in the Centre for Nutrition and Food Sciences at the University of Queensland.
Dr Rebecca Forster is a Postdoctoral Research Fellow in the School of Chemical Engineering at the University of Queensland. f

Words by Deon Mahoney
Managing the safety of our food supply has been a challenge for as long as anyone can remember. So, to navigate contemporary challenges and secure a safe food future it is wise to look back over what we have achieved over recent decades. To do this, I have divided the past 75 years into eras, with a focus on the relationship between the development of our processed food industry and advances in the way we manage food safety.
The eras cover the immediate postwar period (1949-1973), which saw the rapid growth of our food industry; the golden years of food microbiology (1974-1998); and the risk analysis era (1999-2023). I then look to the future (2024-2048) and consider the headwinds we face.
During the post-war era, the Australian food industry was focused
on establishing a modern food processing sector and addressing the demand for new and innovative products. In 1951, Dr Ian Clunies Ross (CSIRO) highlighted the significant prospects for Australian agriculture and food production and the value of science to industry in an early edition of Food Technology in Australia 1 He also signalled the need for scientific research and more training in food technology. Fortunately, a range of tertiary curricula in food science and food technology were being established at this time, starting with educational programs at the Sydney Technical College, then the University of New South Wales, Hawkesbury Agricultural College and Gatton College.
This era saw Australian consumers able to access an increased range of processed foods. There were also changes in the way food was sold, with the corner grocery store making way for the introduction of
supermarkets and self-serve shopping. Fast food entered the marketplace at this time - in 1969, Kentucky Fried Chicken was introduced, and was quickly followed by Pizza Hut, McDonald's and Red Rooster.
The Australian food landscape was changing quite significantly, and the influx of European migrants also changed the type of food consumed. This era saw an explosion in the way food was marketed, without the guiderails of standards regulating health claims or requirements to provide information enabling consumers to make healthy choices. Additionally, this era also presaged increasing interest in food safety, with consumer concerns about chemical and microbiological hazards starting to emerge. To address global concerns, the Codex Alimentarius Commission was established in 1963, signalling international interest in regulating and supporting food safety and quality.
The next 25 years saw the food industry focus on enhancing food quality and protecting consumers from contaminated and unsafe food. Finished product testing made way for quality assurance and food safety programs, with the goal of seeking to identify food safety problems at source. This led to preventative approaches for managing chemical, microbiological, and physical hazards, with the hazard analysis critical control points (HACCP) system a key component of efforts to address food safety.
In the 1980s, the Model Food Act was introduced, the National Food Standards Council was created, and the Australian Food Standards Code was published. While food regulations had been around since Federation, this period saw AIFST and CAFTA supporting the NHMRC in introducing food standards to regulate the safety and the quality of the food supply. In 1991, the National Food Authority Act (FSANZ Act 1991) was established with the goal of establishing and unifying food standards.
With an increased focus on food safety, this era heralded the first major food recalls. A batch of Clostridium botulinum contaminated canned mushrooms was the first major food recall in the United States, with over 75 million cans of mushrooms recalled. Widespread publicity at the time demonstrated an increasing interest in managing food safety.
In Australia, a major outbreak of salmonella infection in 1977 was traced to contaminated milk-based infant formula. This incident resulted in heightened interest in analytical methodologies and increased testing of raw materials and manufacturing environments. The work was chronicled in the paper The year of the salmonella seekers 2
Working behind the scenes during this period was a dedicated group of food microbiologists – located at CSIRO, UNSW Sydney, in various state departments of health, and
the private sector. Their outputs mark this period as the golden age of food microbiology in Australia. These scientists were improving our knowledge of an increasing array of foodborne pathogens and establishing the means by which the food industry could both test and control these hazards.
Unfortunately, a series of outbreaks over consecutive years leading up to 1999 continued to plague the food industry, placing it under greater scrutiny. This included outbreaks of hepatitis A in oysters in 1977, of Shiga toxigenic E. coli (STEC) in mettwurst in 1995 and Salmonella in orange juice in 1996. Public confidence in the food supply was starting to decline, and these incidents played a significant role in changing food regulation in the next era.
The start of this era was characterised by the establishment of Food Standards Australia and New Zealand and the joint Australia New Zealand Food Standards Code. Work commenced on the development of through-chain primary production and processing standards based on a formal risk analysis model. Standards were developed for a range of commodities, including seafood, poultry meat, eggs, meat and horticulture products. Plus, the first approvals were given for GM foods and the irradiation of selected foods.
This period saw international agreements on a structured approach to identify, quantify, and manage risks presented by microbiological hazards. The process of hazard analysis evolved to science-based risk assessment, which not only considered the severity of a hazard but also the likelihood of its occurrence. WHO and FAO led the way, undertaking complex risk assessments on specific pathogen: food combinations, such as Salmonella in poultry meat, Campylobacter in poultry meat, and Vibrio parahaemolyticus in seafood. This work was then used to inform the development of national and
international food standards and guidelines.
Technological innovation also advanced during this period, supporting major improvements in production and processing. We observed the commercialisation of technologies such as high-pressure processing, the use of smart films and packaging and the utilisation of alternative proteins. Machine learning, robotics, and the internet of things resulted in improvements in efficiencies and the amount of data that is now captured enables faster and smarter decisions which bear on food quality and safety. Improved and more cost-effective diagnostics have assisted in enhancing product safety and getting products to market faster.
However, this period has also seen the introduction of disruptive innovations that have changed the way food is manufactured, supplied, and served, often with significant food safety implications. Plus, the focus on food safety has expanded to include lifestyle issues, nutrition, sustainability and food security.
What do we see on the horizon and what are the future food safety challenges? Predicting and contemplating what will emerge over the next 25 years is complex given the pace of change. Given the uncertainties, it is useful to consider some of the challenges and the opportunities they may present:
• Our microbes will evolve, with previously harmless organisms presenting risks to vulnerable groups or evolving into virulent pathogens. Additionally, the ongoing emergence of antimicrobial resistance represents a major threat to public health. While we have made significant inroads into reducing the incidence of salmonellosis, the rates of campylobacteriosis continue to rise and the incidence of listeriosis and other foodborne pathogens remains relatively static
• We will have more vulnerable

consumers, with possibly 25% of the population in this category (the young, old, pregnant, and immunocompromised). As a food industry, we need to consider their needs and better manage their exposure to foodborne pathogens
• Climate change will continue to impact agriculture and the broader food industry, with increasing temperatures and extreme weather events placing further stress on our food production environment and systems, increasing the risk of animal and plant disease
• Consumption patterns are changing, and we have a cohort of the population that has a poor understanding of foodborne hazards and engages in risky eating behaviours, such as foraging and consuming high-risk raw foods. While we need to better educate consumers on safe eating practices, we need to do so in more effective ways. In the post-truth era, social media influencers are disrupting eating practices and the deficit model of food safety communication is ineffective
• Research will continue to reveal ways to identify and control pathogens, and diagnostics will enhance the industry’s ability to quickly detect and isolate unsafe products, although we are yet to
enter the realm of the tricorder - an advanced multi-function handheld computing and scanning device used to gather data in the Star Trek universe3
• New and exotic ingredients will continue to enter the food supply, taxing our risk assessment processes.
Fortunately, public perceptions around food safety remain strong in Australia. The FSANZ food Consumers Insights Tracker found farmers and producers were amongst the most trusted and 72% of people reported confidence in the safety of the food supply.4 This is a good result given we are in a period of great mistrust about science and science communication.
While the incidence of foodborne illness remains stubbornly high, we have all the tools at our disposal to tackle this problem. Our riskbased food safety programs, our diagnostics and a well-trained workforce can address both existing and emerging hazards. But the devil is in the detail. Recent incidents in Australia and overseas could have been avoided if effective risk management was in place. Were we asleep at the wheel? Are we not identifying potential and emerging hazards and the risks they present? Was our process control effectively
implemented and evaluated? The answer is often no!
While we have the tools necessary to address these issues, it largely comes down to management commitment to food safety and the provision of sufficient human and technical resources to support safe food.
I remain very positive about our ability to address food safety in the future; we just need to embrace change and address the challenges. As Noam Chomsky said ‘Optimism is a strategy for making a better future’.
1. Clunies Ross, I. (1951). The future of the food industry in Australia. Food Technology in Australia, Vol. 3, No. 3, pp 55-61
2. Forsyth, J. et al. (2003). The year of the Salmonella seekers-1977. Australian and New Zealand Journal of Public Health, 27, pp 385389
3. https://memory-alpha.fandom.com/wiki/ Tricorder
4. Food Standards Australia New Zealand. (2024). FSANZ Consumer Insights Tracker 2023: Technical Report. Canberra, Australia and Wellington, New Zealand.
Deon Mahoney is a food safety consultant at DeonMahoneyConsulting and is Adjunct Professor in the School Of Agriculture and Food Sustainability at the University of Queensland. This article is based on the author’s Keynote Address at the AIFST Annual Convention, August 2024. f

Australia’s target to halve food waste was committed to by the Australian Government in 2015 when it adopted the United Nations Sustainable Development Goals (SDG). The target (SDG 12.3) is critically important because delivering against it will provide sizable economic, environmental and social benefits for Australia.
End Food Waste Australia (EFWA) is tasked with delivering Australia’s National Food Waste Strategy and has just released its 2024-2030 Strategic Business Plan. The plan outlines exactly what is needed to hit this critical target and what it will deliver for people, the planet and industry profitability. In doing so Australia is one of the few countries with a costed business plan for achieving SDG 12.3.
EFWA has used impact modelling,
academic rigour, extensive expertise and industry collaboration to outline what is needed, what it will cost, and what impact we can achieve together. The evidence is clear: food waste action is vitally important and offers significant benefits.
Food waste is a national issue that exacerbates hunger and financial strain for millions of Australians. Households carry 53% of Australia’s food waste bill - $19.3 billion a year or an average of $2,500 per household.1 We also know that through industry food waste action, we can help provide millions more meals each year to support the 3.7 million foodinsecure households in Australia.2
There are billions of dollars in economic benefits available to
Australian businesses through food waste action. We have seen this in action with Australian Food Pact signatories saving a collective $60 million in 2023 alone through food waste reduction.3 By 2030, halving food waste could provide savings to Australian businesses of more than $1.2 billion.3 For individual businesses, this may mean $7-21 return per $1 invested in food waste reduction.4
With food waste generating up to 10% of global greenhouse gas emissions, food waste action is climate action.5 Halving food waste in Australia by 2030 could prevent 50 million tonnes of CO2-e emissions, which is the equivalent of removing half the vehicles from Australian roads for a year.3 Addressing food waste also alleviates pressure on water-stressed communities and safeguards precious natural resources and biodiversity.
The new 2024-2030 Strategic Business Plan outlines what’s needed, the financial investment, the partnerships required and the systemic changes that will help Australia halve food waste by 2030. It is possible but with less than six years to go, we need action now. This must include:
End Food Waste Cooperative Research Centre will deliver $19 million in new high-impact research and development projects, graduate 40 future leader postgraduates and enhance research extension through commercialisation and communications to provide the knowledge and evidence-based solutions needed to address Australia’s most pressing food waste challenges.
End Food Waste Australia’s Industry Action program – brought to life through the Australian Food Pact and Sector Action Plans – is the driving force behind transformative

food waste action and collaboration across businesses, supply chains and sectors. Supporting industry to tackle food waste is critical to reaching this target.
The Australian Food Pact has an incredible 40 signatories after its first three years and aims to recruit another 34 new food industry signatories, to take its representation to nearly 30% market penetration of post-farmgate food businesses across Australia.3 This ambitious target is projected to deliver $1.2 billion in economic benefits to Australian Food Pact signatories by 2030.3
Implementing the existing 10 Sector Action Plans, which provide comprehensive guides for sectors such as bread and bakery, dairy, horticulture and foodservice, and delivering 12 new Sector Action Plans for the remaining food waste hotspots in Australia, will be critical to Australia’s success.
To accomplish this, the Industry Action pillar requires $27 million in new funding over the next five years, along with support from all
food businesses through joining and supporting the Australian Food Pact and Sector Action Plans.
Australia has not yet seen a coordinated, nationally consistent, unified behaviour change strategy to help Australian households reduce their food waste. This is needed as households contribute 32% of Australia’s annual food waste and foot more than $19 billion of the annual bill.1 What’s more, Australian households are reported to be the second worst food wasters in the world, wasting an average of 102kg per person per year. Only Saudi Arabia reports higher levels of household food waste.6
The Federal Government has demonstrated national leadership by providing seed funding for the development, launch and first-year implementation of a nationwide consumer behaviour change campaign. Over the next five years, securing multi-year base campaign funding and support from across the food industry will be
key in continuing to enable broad stakeholder support at scale.
A total investment of $66.9 million is essential to achieve genuine and enduring behaviour change in households.3 This can deliver savings of $2,500 per household and be a major contributor to reducing household food waste by 30%, which is required for Australia to hit its overall 50% national reduction target.3
An investment of $8.9 million over the next five years in strategy, policy and growth activities will enhance our ability to provide evidence-based policy support, develop innovative strategies and foster sustainable growth. This will start with supporting the recommendations of the Federal and state government enquiries into our food system and food insecurity, such as the implementation of the food donation tax incentives. This investment will ensure we remain at the forefront of driving change and creating a lasting impact on Australia’s food system.
Along with an investment of $8.6 million over the next five years to fund central marketing, communications and stakeholder engagement efforts, $135 million in new funding is required between 2025 and 2030 to achieve SDG 12.3. That equates to $22.4 million/year.
To understand the impact of each of these initiatives, we modelled the expected food waste reduction of each action up to 2030. This involved first mapping each action to its relevant sector and commodity, then taking the known food waste volumes for that sector or commodity and applying a percentage reduction over the time period that each action will be implemented. The percentage reductions were either informed by research, existing reports, observations from current initiatives, or expert opinions gained over the first six years of the organisation’s operations.
The required $135 million budget has been developed based on a similar method, using a bottom-up evidence-based approach based on the return on investment we have achieved from our first six years of activities as a guiding principle.
Through this process, we predict the actions described in the 2030 Strategic Business Plan will reduce food waste by a combined 2.5 million tonnes in 2030. When considering that current funding and initiatives are already projected to achieve a 1.4 million tonne reduction in 2030, the combined activities driven by EFWA and our partners are estimated to reduce food waste by 3.9 million tonnes in 2030, closing in on the 2030 national target of 4.6 million tonnes. The remaining 0.7 million tonnes are predicted to be delivered by nonEFWA activities by industry and governments.
The 2030 Strategic Business Plan shows a clear path towards achieving the National Food Waste Strategy and UN SDG 12.3 targets. It shows us that it is possible and that the actions and funding to get there are realistic.


But we cannot deliver this target or our vision of an Australia without food waste alone.
It will require prioritising food waste action and collaboration and partnership from governments, NGOs, research organisations, industry and all Australians.
The call to action is clear: unprecedented collaboration and investment are crucial. Together, we can turn the tide on food waste, ensuring a sustainable, resilient and prosperous future for all Australians.
We invite you to join us to end food waste!
References
1. End Food Waste Australia (2022) Costed business case for a nationwide consumer behaviour change campaign: Household food
waste: Why we need to act now.
2. Foodbank Australia (2023) Foodbank Hunger Report. https://reports.foodbank.org.au/ foodbank-hunger-report-2023/
3. End Food Waste Australia (2024) 2024-2030 Strategic Business Plan. https://endfoodwaste. com.au/wp-content/uploads/2024/07/EFWAStrategic-Business-2024-2030.pdf
4. FIAL (2021) National Food Waste Strategy Feasibility Study. https://www.fial.com.au/ sharing-knowledge/food-waste
5. United Nations Environment Program (UNEP) (2021) Food Waste Index Report 2021
6. Economist Impact (2021) Food Sustainability Index based on data from UNEP. https://impact. economist.com/projects/foodsustainability/g20/ fixing-food-2021-infographic
Dr Melanie Hand is Data and Reporting Manager and Dr Steven Lapidge is CEO at End Food Waste Australia. f

Pineapple (Ananas comosus), often celebrated as the ‘king of tropical fruits’, has long delighted consumer taste buds with its sweet and exotic flavour. Recent research reveals that its appeal extends beyond taste to include aroma. Funded by Hort Innovation, a team of researchers from the Queensland Department of Agriculture and Fisheries (QDAF) and the Queensland Alliance for Agriculture and Food Innovation (QAAFI) at the University of Queensland (UQ) studied the aromatic compounds within Australian-grown pineapple cultivars. These findings revolutionise our understanding of the sensory qualities hidden within this tropical fruit.
When a pineapple ripens, it undergoes intricate chemical changes. Carbohydrates, amino acids, and other compounds transform into smaller molecules known as
volatile organic compounds (VOCs).
A comprehensive literature review revealed approximately 500 VOCs and 40 key aroma compounds in pineapple cultivars.1
The QDAF-QAAFI research team developed an advanced analytical method to quantify these key aroma volatiles. Their approach combines state-of-the-art techniques, including Head Space (HS)-Solid Phase Microextraction (SPME), Gas Chromatography coupled with Mass Spectrometry (GCMS), and stable isotope dilution assay (SIDA).
The team’s groundbreaking work was published earlier this year in the journal Food Chemistry 2
Accurate quantification of aroma compounds sheds light on their role in fruit sensory qualities and genetic pathways. Aroma compounds vary across pineapple varieties. By
“Key aroma compounds— responsible for a staggering 80% of pineapple’s flavour perception— are among these VOCs. These elusive molecules hold the key to the fruit’s irresistible fragrance and significantly impact consumer acceptance” (Professor Heather Smyth, Principal Research Fellow, QAAFI-UQ).
measuring VOCs, researchers can identify the genes controlling their formation and profile.
Applying their published methods, the team compared sugar content (measured as °Brix), acidity (measured as % titratable acidity) and aroma profiles of five Queenslandgrown pineapple cultivars:
1. ‘Aus Carnival’
2. ‘Aus Festival,’
3. ‘Aus Jubilee,’
4. ‘Aus Smooth (Smooth Cayenne)’
5. ‘Aussie Gold (73-50)’
The results were illuminating. VOCs
“Armed with this knowledge, we can selectively breed pineapple varieties with superior flavour or focus on prized aromatic characteristics” (Dr Garth M Sanewski, Principal Horticulturist, Sub-Tropical Fruit Production Systems, QDAF).
correlated with fruit ripeness and cultivars with higher sugar-to-acidity ratios exhibited more volatiles. Specific key aroma compounds, such as methyl and ethyl esters, and terpenoids such as alpha-terpineol, limonene and damascenone, had good sensory appeal. ‘Aus Festival’ and ‘Aus Jubilee’ emerged as the most preferred by consumers, while ‘Aus Smooth’, with its lower sugarto-acidity ratio and reduced levels of certain compounds, was least preferred.3
“Rigorously validated against international quality standards, this novel method promises high throughput for daily applications, surpassing existing techniques” (Jenson George, Senior Research Scientist QDAF).
Queensland produces all Australiangrown pineapples, and the sector is valued at about $76 million per annum. This research could open doors to a pineapple breeding revolution.
Thanks to the research, consumers can look forward to enjoying pineapples that transport them to a tropical paradise. The findings provide insight into the symphony of fragrant molecules crafted by nature that are behind every juicy bite. This work forms part of the project ‘Genetics of Fruit Sensory Preference (AS19003)’ which is funded by the Hort Frontiers Advanced Production Systems Fund as part of the Hort Frontiers strategic partnership initiative developed by Hort Innovation, with co-investment from the Queensland Government,

State-of-the-art GCMS technology is being utilised to analyse the volatile organic compounds (VOCs) present in pineapples. Jenson George from the QDAF is examining the key aroma compounds for their aroma profiles through the olfactory detection port (ODP) while the GCMS conducts real-time analysis. (Image credit: Professor Heather Smyth, QAAFI-UQ).

Sensory scientist, Ishita Pramanik from QDAF conducting an analysis of the flavour profiles of different pineapple cultivars. (Image credit: Consumer and Sensory team, QDAF).
QAAFI-UQ, Griffith University and contributions from the Australian Government.
1. George, J., Nguyen, T., Williams, D., Hardner, C., Sanewski, G., & Smyth, H. E. (2023). Review of the aroma chemistry of pineapple (Ananas comosus). Journal of Agricultural and Food Chemistry, 71(9), 4069-4082. https://doi. org/10.1021/acs.jafc.2c08546
2. George, J., Nguyen, T., Sanewski, G., Hardner, C., & Smyth, H. E. (2024). Stable isotope dilution assay and HS-SPME-GCMS quantification of key aroma volatiles of Australian pineapple (Ananas comosus) cultivars. Food Chemistry, 139956. https://doi.org/10.1016/j.foodchem.2024.139956
3. QDAF, Consumer and Sensory Research Team, led by Philippa Lyons, 2023.
The project team wishes to thank Favco Qld for supplying the fruit
used in this study.
Jenson George is an analytical chemist and Senior Research Scientist leading the Food Chemistry team of Queensland Department of Agriculture and Fisheries. Mr George specialises in flavour chemistry through his PhD studies titled ‘Tropical fruit flavour chemistry’, under the supervision of Professor Heather Smyth at Queensland Alliance for Agriculture and Food Innovation, The University of Queensland. f

Words by Frances Warnock
It is estimated that 733 million people may have faced hunger in 2023.1
With just six years until 2030, the target date set by UN Sustainable Development Goal (SDG) 2 to achieve zero hunger, trends are not moving in the right direction to end hunger and food insecurity. Everyone, everywhere should have the right to diverse, nutritious, affordable and safe food every day to achieve good health and live a productive life.
‘Leave no one behind’ is more than a slogan; it’s a call to action for governments, development partners, the private sector, civil society, researchers and academia to ensure that all individuals, especially the most marginalised, poor and vulnerable people, including infants, have access to safe, nutritious and sufficient food all year round.
Food safety is a key pillar of food security and a primary determinant of human health. Ensuring food safety is central to achieving all 17 SDGs by 2030.
Foodborne illness (FBI) is a serious health and economic problem
FOOD SAFETY ISSUES
Perishable seafood stored on the ground at ambient temperatures until sold
Lack of refrigeration, cool storage facilities
Lack of clean safe water for drinking, handwashing and maintaining vegetables fresh
Food waste and plastic packaging builds up around central food markets
throughout the world and hinders progress towards achieving SDG 2 Zero Hunger by 2030. Around 600 million people fall ill each year and about 420,000 die as a result of eating contaminated foods. In Asia Pacific, there are about 275 million cases of FBI each year and an estimated 225,000 deaths. Most at risk are vulnerable women, the elderly, the immunocompromised and young children. Children under five years old make up 9% of the world’s population but carry 34% of the burden of foodborne disease, being at a higher
White tiled benchtops installed one metre above ground. Use clean ice in storage bins
Solar powered refrigeration and short supply chains
Installation of large potable water tanks at central markets for vendors
Gizo markets successfully banned all plastic packaging
risk of malnutrition and mortality due to eating unsafe food.2
‘If it’s not safe, it’s not food’
More than 90% of women’s employment in low-middle income countries (LMIC) is in the informal economy. Smallholder farmers produce around one-third of the world’s food. Women play a vital role in producing and selling food for domestic markets, from small



Solomon Islands traditional foods sold in local markets – L-R sea grapes, edible ferns and Lao ethic Hmong woman harvesting riverweed for Kaipen.
rural farmers, market vendors, street food vendors, school meals ‘caterers’ and household cooks. For many developing countries, unsafe food in informal channels accounts for a large majority of foodborne diseases attributed to marketed food. Most meat, milk, eggs and fish produced in developing countries are sold in traditional, domestic markets lacking modern infrastructure and escape effective food safety regulation, inspection and control.3
There is a lack of published information on traditional food systems, including food safety risks.4
Food safety awareness, training and education are fundamentally important for all actors across food value chains. Food handlers should be aware of their roles and responsibilities in protecting food from contamination and preventing foodborne diseases. In many LMIC in Asia Pacific there is still limited availability of food safety training, especially for adults from diverse cultural, linguistic and educational backgrounds.
Addressing food safety from a people-centred approach involves preventive approaches informed by evidence and a sound understanding of the drivers and barriers to Social and Behaviour Change (SBC).
Give a woman a fish you feed her family for a day. Teach a woman to produce safe and nutritious foods you feed her whole community for a lifetime! Frances Warnock
Effective communication is vital, listening to the voices of all people, diverse languages and communication channels.5 Qualitative behavioural observation studies conducted in the field, community consultations and focus group discussions provide valuable insights into local food safety issues and concerns. Information gathered from behavioural studies informs the development of relevant and meaningful food safety programs, messages, materials and communication channels.
Adult learning methods including interactive participatory approaches, practical demonstrations, facilitated group discussions and field visits to local food markets are more effective approaches than delivering food safety technical information as formal lectures. Food safety training requires careful planning with national government counterparts (food, agriculture, health and education), local community leaders and civil society organisations to ensure training meets local community needs.
Case study: National School Meals Programme (NSMP) in Sri Lanka
The Sri Lankan National School Meals
Programme (NSMP) serves all 1.7 million primary school children in Grades one-five a freshly cooked healthy meal every day before classes begin. Meals are prepared by home and school ‘caterers’ (around 18,000) across the country. But how safe is the food served to children at school? Contaminated food can negatively impact children’s mental and physical development and general well-being. Food safety risks associated with school meals are not necessarily assessed or addressed at all points, other than the physical characteristics of the cooking premises, which means there is the potential for children to fall ill.
In 2021, WFP Sri Lanka developed a food safety training package for capacity-strengthening activities with the support of the Australian Volunteers Program (AVP). In 2022, Food Safety Guidelines for School Meals were prepared following a Food Safety Risk Assessment Study of NSMP supported by the World Food Programme (WFP).
Unfortunately, the commitment that prevails at high levels of government to ensure the safety of the food prepared and served as part of NSMP has not translated to an implementation plan for strengthening


Training workshops on postharvest management of food safety and nutrition in Solomon Islands for ‘Sup Sup’ home gardeners, smallholder farmers, market vendors, women’s groups, youth and agriculture extension officers (FAO 2023).
the capacity of relevant food inspectors and school caterers. This means that there is limited priority given to, or technical and financial resources provided for, Public Health Inspectors at district level to train and inspect caterers’ homes for food safety certification.
1. FAO, IFAD, UNICEF, WFP and WHO.( 2024) The State of Food Security and Nutrition in the World 2024 – Financing to end hunger, food insecurity and malnutrition in all its forms. Rome. https:// doi.org/10.4060/cd1254en
2. Strengthening sector policies for better food security and nutrition results. http://www.fao. org/3/ca9476en/ca9476en.pdf
3. Jaffee, Steven, Spencer Henson, Laurian Unnevehr, Delia Grace, and Emilie Cassou. (2019). The Safe Food Imperative: Accelerating Progress in Low- and Middle-Income Countries. Agriculture and Food Series. Washington, DC: World Bank. doi:10.1596/978-1-4648-1345-0.
4. FAO & University of Wollongong. (2023) National assessment of the Solomon Islands food system. Honiara, FAO. https://www.fao.org/3/ cc4175en/cc4175en.pdf
5. Ngigi, Samuel & Busolo, Doreen. (2018). Behaviour Change Communication in Health Promotion: Appropriate Practices and Promising Approaches. International Journal of Innovative Research and Development. 7. 10.24940/ ijird/2018/v7/i9/SEP18027.
6. Global School Meals Coalition: https:// schoolmealscoalition.org/members-partners/
Frances Warnock is an international consultant on food safety and nutrition capacity strengthening in low-middle income countries in Asia Pacific, Adjunct Fellow UNSW Sydney, School of Chemical Engineering and Returned Volunteer AVP. f
This article is based on the author's presentation at the AIFST Annual Convention, August 2024.
Leave no one behind
Empowering women
Food safety capacity strengthening using a people centred approach
• Good development comes from empowering people with the tools to put their solutions into practice
• ‘Leave no one behind’ is a global vision for translation into many interlinking actions. Priorities must include tackling inequalities related to the availability and access to a diverse range of culturally acceptable, safe and nutritious foods for all.
• Greater awareness and understanding of local food systems, traditional knowledge and cultural practices to inform food security interventions. Prioritize the development agenda of local communities.
• Decent work and financial returns for all women in low-middle income countries, including informal and traditional food sectors.
• Social behavioural research and ‘evidence’ to inform food safety and nutrition interventions, and integration of traditional and modern knowledge.
• Capacity building activities on food safety and nutrition to be available and accessible for all actors across food value chains. Training to be contextual, relevant and meaningful.
• UN Agencies to acknowledge a ‘one-size fits all’ topdown approach is not inclusive or sustainable.
Equal partnerships for sustainable development at global, national, regional and local levels
• Private sector and donors to co-fund food security, nutrition and food safety activities based on capacity to shift the dial towards achieving multiple SDGs within a reasonable timeframe.
• Scaling up ‘pilot projects’ and locally led interventions shown to be successful or good potential to achieve sustainable outcomes by 2030.
• School Meals Coalition6 expanded across the globe and within countries ensuring all children receive a nutritious, safe cooked meal every day at school.
Table 2. Navigating the future to improve food safety and health outcomes for all – Summary and Key Messages.












































Words by Ian Hayes
Packaging technology has always been about devising ways to protect and contain products and to best manage safety for the product’s consumer.
It can surprise some people how central packaging is to many businesses, but when we stop and think about what packaging has to do, this core requirement makes more sense.
Working as a packaging technologist involves understanding and applying new developments that improve the quality of products and the consumer experience. This can include working with:
• Product developers and food scientists to deliver the best packaging formats for each product and ensure product protection
• Quality teams to manage any specific quality issues with packaging
• Manufacturing teams to manage any issues with production line efficiency and packaging machine performance
• Procurement teams to balance cost and performance requirements during packaging selection processes
• Marketing and sales teams to help deliver optimal graphics and shelf appeal, which is key to success
• Regulatory affairs and legal teams regarding legal requirements for certain information
• Logistics teams to optimise packaging through the complete supply chain - from primary pack to shipping carton to pallet utilisation to warehouse and transport optimisation
• Sustainability teams, with packaging a key plank in the sustainability strategy of many companies.
A good packaging technologist is well integrated into their organisation and can provide insights into

all aspects of any company's performance and productivity.
Given such a wide scope of interactions, packaging technologists can come from a variety of disciplines. Science and engineering backgrounds are typical, but others can come from an economics or accounting background (via procurement teams) and environmental science has more recently provided a novel entry point for budding packaging technologists.
The scope of knowledge required for packaging technology is broad. Some days you may need to understand polymer science and the next you may be dealing with geometric shapes when optimising packaging for shelf presence and pallet utilisation. You may be dealing with the chemistry of a failing steel can lining, and then trying to understand the permeability requirements of a packaging material to keep oxygen out and moisture in so as to maintain the product’s shelf life.
To deal with this, it is crucial that the packaging technologist has a thirst for constant learning. This can be via formal education pathways or by subscribing to on-line packaging magazines, which will provide glimpses into what is happening globally and the latest developments in packaging. Attending meetings and conferences is also important. Be sure to engage with the speakers; learn from them and their experiences.
The real key is to learn from your own experiences; the projects that succeed and the projects that have failed will help inform your knowledge for the future. The links between packaging and sustainability are now clear and well understood and, as such, there has never been a better time to be a well-informed and welleducated packaging technologist.
Ian Hayes is Sustainable Packaging Strategist at Australian Packaging Covenant Organisation Ltd. (APCO). f
Words
Australia is one of the largest exporters of red meat. However, market access of lamb meat is constrained by its shelf-life. Vacuum-packed (VP) lamb has approximately half the shelflife of beef under similar storage conditions,1 a difference that remains poorly understood. Beef and lamb have been shown to differ in factors such as pH, fat content and nutrient availability.2 For instance, lamb typically has higher pH and fat content, while its glucose levels, a major source of energy, are lower compared to beef.3,4,5 Together, these factors affect bacterial growth, microbial community compositions, and spoilage rates, ultimately leading to shorter shelf-life.
Red meat microbial spoilage is a complex process involving diverse bacterial communities and their interactions with each other and the meat, as depicted in Figure 1. However, to date numerous studies have focused on using microbial community analysis and metabolomic approaches independently to understand the microbiology of meat spoilage. This limits our understanding of red meat microbial spoilage mechanisms, which underpin the shelf-life difference between beef and lamb. Current research on red meat spoilage has identified dominant spoilage bacteria for each meat type.6 These bacteria consume nutrients on meat and produce various compounds, some of which are correlated with spoilage.7 This demonstrates that microbial community and metabolomic data are closely interlinked. However, these datasets have not yet been integrated to provide a comprehensive understanding of the differences in shelf-life between beef and lamb.
To address this knowledge gap, our

research focuses on understanding changes in red meat metabolomes as they relate to the development of the microbial spoilage community. The results of this study will provide scientific knowledge underpinning the shelf-life differences between beef and lamb. In future, these insights can be used to develop targeted approaches to assure and/ or extend the quality shelf-life of VP meat, ensuring food security and reducing wastage.
1. Sumner, J., P. et al. The changing shelf life of chilled, vacuum-packed red meat. In Food safety and quality-based shelf life of perishable foods, P.J. Taormina and M.D. Hardin, Editors. Springer International Publishing: Cham. 2021; pp. 145-156.
2. Toomik, E., L. et al. Microbial spoilage mechanisms of vacuum-packed lamb meat: A review. Int. J. Food Microbiol., 2023. 387, 110056 https://doi.org/10.1016/j.ijfoodmicro.2022.110056.
3. Immonen, K. and E. Puolanne. Variation of residual glycogen-glucose concentration at ultimate pH values below 5.75. Meat Sci., 2000. 55(3), 279-283 https://doi.org/10.1016/S03091740(99)00152-7.
4. Williams, P. Nutritional composition of red meat. Nutr. Diet., 2007. 64(S4), S113-S119 https://doi. org/10.1111/j.1747-0080.2007.00197.x
5. Jacob, R.H., et al. Muscle glycogen concentrations in commercial consignments of Australian lamb measured on farm and postslaughter after three different lairage periods. Aust. J. Exp. Agric., 2005. 45(5), 543-552 https://doi.org/10.1071/EA03216.
6. Kaur, M., M. et al. Effect of abattoir, livestock species and storage temperature on bacterial
community dynamics and sensory properties of vacuum packaged red meat. Food Microbiol., 2021. 94, 103648 https://doi.org/10.1016/j. fm.2020.103648.
7. Ercolini, D., I. et al. Monitoring of microbial metabolites and bacterial diversity in beef stored under different packaging conditions. Appl. Environ. Microbiol., 2011. 77(20), 7372-7381 10.1128/AEM.05521-11.
Some of the results of our research were submitted for the AIFST 2024 poster competition. The authors of the poster were:
Elerin Toomik is a PhD student at Centre of Food Safety and Innovation (CFSI), Tasmanian Institute of Agriculture (TIA).
Dr Laura Rood is a postdoctoral research fellow at CFSI, TIA.
Dr Richard Wilson is a Senior Research Fellow at the Central Science Laboratory.
Professor John P. Bowman leads the CFSI, TIA.
Dr Chawalit Kocharunchitt is Senior Research Fellow and lecturer at CFSI, TIA.
All are at the University of Tasmania Their poster won the AIFST 2024 Research Poster Competition and is available here: https://www.aifst.asn. au/resources/Documents/Awards/ posters24/26.%20elerintoomikAIFST24-POSTER.pdf. f
Words by Dr Nelum Pematilleke, Dr Lukas Danner and Dr Ha Truong
Aquaculture in Australia is a rapidly growing sector, currently making up 42% of the nation’s fisheries and aquaculture production, with projections to reach 64% by 202829.1 Despite being a major exporter of premium, sustainably produced seafood, Australia remains a net importer, bringing in $2.58 billion worth of seafood, primarily lowervalue products such as canned and frozen finfish.2,3 This highlights an opportunity for Australia to reduce its reliance on imports by focusing on native, high-quality seafood production.
Australia can reduce its reliance on imported seafood by producing native, affordable species such as Jade perch, which aligns with its 'clean and green' reputation. Native to Central Australia’s Barcoo River, Jade perch grows well in land-based farms, thrives on a plant-based diet and reduces the need for wildcaught fish feed. With relatively high omega-3 content (2483mg per 100g)4 compared to other whitefleshed, Jade perch is a strong contender for the market.
There is, however, a lack of comprehensive documentation regarding the sensory properties of Jade perch and how it compares with other widely available, white-fleshed fish species. The effects of growing conditions, which can influence sensory properties and potentially consumer acceptance, remain largely unexplored. The current work aimed to characterise and compare the sensory profiles of Jade perch and quantify the influence of various aquaculture practices and diets.
A quantitative sensory descriptive analysis was conducted in two stages by an experienced and trained panel (n=9). Stage one characterised the sensory properties of Jade perch and contrasted them with other

commercially available, white-fleshed fish species. Stage two investigated the effects of diet composition, fasting, and water conditions on the intensity of key sensory attributes of Jade perch.
The results of the first stage showed that Jade perch fish shared a similar flavour profile with commercially farmed Barramundi and Murray cod, indicating strong market potential. However, the fish exhibits some earthy characteristics, including muddy and grassy notes, often found in river fish, which the second stage of the study aimed to address.
Stage two results showed that the different diet and purging conditions influenced some of the key sensory attributes of the Jade perch fish. Jade perch that were purged for 21 days in high salinity conditions (15 ppt) post-harvest had significantly lower muddy and grassy flavours compared to the fish cultured in low salinity (0 ppt) and not purged, and farmed fish. This finding suggests water salinity could be considered to ameliorate muddy, grassy off-notes, which may detract from consumer acceptance.
This study indicates that Jade perch has potential as a new commercial, white-fleshed aquaculture species when grown appropriately, and could add a good source of Omega-3 fatty acids to
Australian and global diets. Jade perch is an ideal species for adopting eco-conscious aquaculture practices, which include repurposing waste into fish feed and using fish-rearing water to cultivate crops, illustrating an integrated approach like aquaponics.
1. Tuynman, H., Dylewski, M., Cao, A., & Curtotti, R. (2024). Australian fisheries and aquaculture outlook to 2028 29, ABARES research report, Canberra, March, DOI: https://doi.org/10.25814/ hz34-bh86. CC BY 4.0.
2. FRDC (2024a) Australian Seafood Trade and Market Access. Fisheries Research and Development Corporation web article. Updated 23 July 2024. DOI: https://www.frdc.com.au/ australian-seafood-trade-and-market.
3. FRDC (2024b) Australian Seafood Trade Dashboard. Fisheries Research and Development Corporation Statistic database. Updated 1 March 2024. DOI: https://www.frdc.com.au/australianseafood-trade-dashboard.
4. Sawant, S., Chavan, B. R., & Kamble, M. (2018). Introduction of Australian Jade perch culture in India; Lesson to be learned from east Asian countries. Contemporary Research in India, 3(23).
Dr Nelum Pematilleke is a sensory and consumer science research technician, Dr Lukas Danner is the team leader for the sensory and consumer science team and Dr Ha Truong is a research scientist in Aquaculture Nutrition. All are at CSIRO.
Their poster was runner-up in the AIFST 2024 Research Poster Competition and is available here: https://www.aifst.asn.au/ resources/Documents/Awards/ posters24/18.%20CSIRO%20Jade%20 Perch.pdf. f








With 12 Internal and Lead Auditor courses on offer, including ISO and BRCGS, we are Australia’s leading provider of Food Safety, HACCP, GFSI and ISO training courses.
Our extensions program enables our students to extend their training into Lead Auditor qualifications from our 2-day Internal Auditor courses.
All of our Lead Auditor courses are Exemplar Global accredited, excluding BRCGS. QMS Audits is a Registered Training Organisation (RTO. 45344)
Call us for a chat to understand your next step to becoming an auditor.
OUR 2024/2025 AUDITOR ACADEMY COURSE LINE-UP INCLUDES
Internal Auditor – Food Safety
Lead Auditor – Food Safety
Internal & Lead Auditor – ISO 14001 – Enviro
Internal & Lead Auditor – ISO 9001 ISO 19011
Internal & Lead Auditor – ISO 45001 – OHS
IMS Implementation & Lead Auditor –ISO 9001, 14001 and 45001
BRCGS Auditor – 3 & 5 day
Audit a Cook Chill Process – FBPAUD5002
40 Hours of Food Microbiology
Combined Food Microbiology and Cook Chill